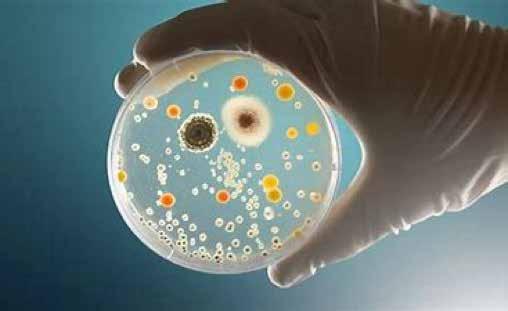

ás de treinta años han transcurrido a nivel mundial en investigación teórica y aplicación práctica, tendiente a desarrollar aceites y grasas más saludables y funcionales con un menor contenido de ácidos grasos saturados, grasas trans y resaltar atributos favorables específicos para cada semilla, grano y producto oleaginoso.
En este punto nos encontramos hoy en día y es evidente que se han registrado cambios sobresalientes. Desde entonces, los procesadores mexicanos siguen las recomendaciones, acordes con los adelantos científicos que responden a los requerimientos del consumidor; tener materias primas de calidad y la posibilidad de elaborar cientos de productos alimenticios destinados al consumo humano, así como nuevas fórmulas para piensos que se utilizan en cada una de las especies animales, incluyendo la acuacultura.
El primer eslabón de esta muy amplia y compleja cadena productiva inicia en los campos agrícolas con productores que trabajan la tierra con el fin de lograr cosechas abundantes y sustentables para una población en constante crecimiento. Es importante resaltar que las empresas aceiteras en nuestro país, invierten recursos económicos y técnicos en la búsqueda de nuevas variedades de granos y semillas oleaginosas que estén bien adaptadas a las condiciones climáticas, edafológicas y disponibilidad de agua, entre otros requerimientos, para producir, por ejemplo: soya, canola, cártamo o palma de aceite, con un mejor perfil de ácidos grasos, mayor calidad nutricional, funcionalidad y, vida de anaquel en productos terminados.
La disponibilidad de aceites y grasas vegetales que se producen en México responde, desde luego, al dinamismo de los mercados mundiales y a los cambios en la dieta de un consumidor cada vez más informado, más exigente y que requiere alimentos con altos estándares de calidad.
Sin duda, la integración regional lograda desde la firma del TLCAN, hoy T-MEC, fortaleció la posición de la industria aceitera mexicana, al tiempo de colocarla en un mercado global más competitivo y demandante, en donde las disposiciones quedan establecidas en normas internacionales y locales mexicanas.
En la actualidad, la industria aceitera cumple con el etiquetado frontal fortaleciendo la información que recibe el consumidor. También establece altos estándares de calidad para los aceites y las grasas que se comercializan en el mercado nacional de acuerdo con el Sistema Nacional de Infraestructura de la Calidad a través de normas mexicanas en el contexto de la normatividad regulado por el Códex Alimentarius de las Naciones Unidas.
Aunque hoy contamos con una oferta de aceites y grasas favorables que producen las empresas procesadoras y, se aplican en diferentes productos para su consumo humano, ya sea en instituciones, restaurantes y uso doméstico, la investigación y desarrollo debe seguir su marcha y continuar su trabajo en cada eslabón que integra esta cadena y contribuye a tener una dieta más diversa, con alimentos de menor costo, mejor sabor, aroma y textura; pero, sobre todo que sean más saludables.
· Continúa el dinamismo en la oferta de aceites y grasas saludables.
· El aceite alto-oleico ofrece nuevas soluciones para una alimentación más saludable.
· El Código de Prácticas (CoP) del Codex Alimentarius, recomienda seguir algunas estrategias para reducir los 3-MCPDEs y GEs de los aceites refinados.
· Lipidómica.
·Biodiesel.
· Indonesia realiza pruebas en carretera con biodiesel B40 de palma de aceite.

· La Mariposa Monarca aparece en la “lista roja” de las especies en peligro de extinción.

· Hace 500 años, Magallanes y Elcano lograron la primera circunnavegación de la Tierra.
· Día Mundial de la Agricultura: acciones y recomendaciones.
· El aceite de argán contribuye al desarrollo de Marruecos, y destaca el papel de las mujeres de la región.



· Resistencia antimicrobiana: una amenaza invisible.



· High Oleic Oils: Development, Propeties, and Uses, Frank J. Flider



· Pronto la Tierra entrará en la era Novacene de la super-inteligencia.
· Repensar la pobreza: Un giro radical en la lucha contra la desigualdad global.
· Sorprendente pirámide de cabras trepadas en un argán.

· Los productores del Norte de Italia logran aceite de calidad a pesar de la sequía y las heladas.
· El vidrio revolucionó la investigación química.
· El sonido ambiental influye en la preferencia y disfrute de los alimentos.

El cártamo (Carthamus tinctorius L.) es una planta de cultivo anual que produce semillas de dos tipos: las naturales y las alto-oleico; estas últimas con bajo contenido de ácidos grasos saturados, muy adecuadas para la extracción de aceite de alta calidad, materia prima para la elaboración de alimentos más saludables y, por su alto punto de humeo, es propio para frituras comerciales.


Año: XXXV Vol. 23 Número 117 periodo: julio / septiembre 2022
Gregorio Gómez Sanz
Octavio Díaz de León
Jorge Terrones López
Mario Vázquez Gaytán Fernando Guareschi
Jorge Ramos Arvizu
Pro Tesorero
Fernando Lisárrague Gireud
Secretario
Amadeo Ibarra Hallal
Enrique García Gámez
Rogelio Lamarroy González Íñigo González Covarrubias
Juan Pablo Castañón Castañón José R. Montenegro Miguel Ángel Couttolenc
Hernando Vergara Gerardo Ortíz Alexander Mena Enrique Gámiz Salido Carlos Morales Paulín
Comisario Ángel Sañudo Álvarez
Coordinador General Amadeo Ibarra Hallal
Consejero Editorial Eduardo López Pérez
Editora
Susana Garduño Oropeza
Diseño y Formación
Ma. Eulalia Gómez Schafler Gabriela García González
Berenice Flores Hernández
Circulación
Carlos A. Sánchez de la Vega Raúl Frías Morales Silvia Hernández Rubín
Todos
Impresión:
de sus autores. Impresa en México
El aceite de girasol (Heliantus annus) alto-oleico se procesó por vez en Rusia, con pequeñas cantidades, a partir de hibridización de la planta y el aceite que se obtuvo se utilizó en aplicaciones especiales. De acuerdo con los datos proporcionados por Frank J. Flider una vez que se comprobó que este tipo de aceite tiene grandes ventajas, muy semejantes al de oliva (Olea europea), los investigadores y procesadores han trabajado intensamente para mejorar y aumentar la producción de aceites alto-oleico, porque entre sus muchas ventajas puede eliminar el proceso de hidrogenación que genera ácidos grasos trans, perjudiciales para la salud, es muy estable y los productos que se fabrican con este aceite tienen mayor vida de anaquel.

En la década de 1990, aumentó el suministro de aceite de oliva que en forma natural contiene importantes cantidades de ácidos grasos alto-oleico (70%-80%), aceite al que se incorporó el de girasol, el primero en ser procesado desde la modificación de la semilla; pero la producción de estos aceites era limitada y su costo muy alto e incosteable para aplicaciones más abundantes y diversificadas. El procesamiento de aceite alto-oleico, por ser un aceite saludable, siguió su marcha, con semillas mejoradas, y con ello, aumentó la producción a niveles de gran consumo, principalmente de girasol, canola y de soya.
Existen varios aceites que en forma natural cuentan con importantes cantidades de ácidos grasos monoinsaturados Omega-9 alto-oleico; entre los que destacan: oliva, aguacate, macadamia, almendra, avellana, cacahuate y pistache.
Una de las características más sobresalientes de los aceites alto-oleico es su estabilidad y alto punto de humeo, lo cual son muy adecuados para muchas aplicaciones: frituras, panadería, repostería, rellenos y emulsiones con la ventaja de tener una larga vida de anaquel.
Los primeros intentos para reemplazar la hidrogenación parcial de los aceites nativos, sobre todo para elaborar mantecas, mezclas, y otras fórmulas fueron infructuosas. Sin embargo, un área prometedora fue la categoría de los aceites alto-oleico, tal como sucede naturalmente en los aceites con importantes cantidades de ácido graso oleico como el de oliva y sus efectos saludables, que demuestran las personas que siguen la “dieta mediterránea”, de larga historia en la alimentación humana. Precisamente, de la palabra ‘oliva’ procede el adjetivo ‘oleico’ para designar el ácido graso oleico y los aceites alto-oleico.
Durante las últimas décadas, los aceites y grasas vegetales han registrado cambios sobresalientes, gracias a los avances en la investigación y el desarrollo de aceites más saludables, y como resultado, alimentos también más saludables por la eliminación de la hidrogenación parcial de los aceites líquidos poliinsaturados, que aumentan en forma significativa los ácidos grasos trans, causantes de incidir en padecimientos

cardiovasculares, un asunto de salud en debate desde las décadas de 1950 y 1960 entre los que participaron investigadores de la AOCS encabezados por el Dr. Fred Kimmerow, equipo que demostró que los ácidos grasos trans son un factor causante de efectos negativos en el sistema cardiaco, evidencias avaladas posteriormente con otros estudios científicos.
Wilhelm Normann patentó en Alemania en 1902 y en Gran Bretaña en 1903 la hidrogenación de aceites líquidos mediante hidrogeno gaseoso, comienzo de lo que se convirtió en una gran industria, por su objetivo central: obtener grasas sólidas a partir del aceite líquido.
Los aceites alto-oleico (naturales o procesados) son ideales para condimentar ensaladas y otros platillos
En la década de 1970 se iniciaron diversos ensayos para la elaboración de mantecas sin tener que acudir a la hidrogenación parcial con la finalidad de producir aceites y grasas con mayor estabilidad, menor oxidación y buenas características físicas, con lo cual fue posible utilizando varias tecnologías; entre éstas, la interesterificación química y la interesterificación enzimática.
El aceite de girasol (Heliantus annus), primer aceite alto-oleico fue elaborado con semillas híbridas que contienen cantidades importantes en ácido oleico -ácidos grasos monoinsaturados Omega-9-. En los últimos años han ganado atención por su
composición en ácidos grasos que proporcionan estabilidad oxidativa y térmica, por su perfil saludable y sus múltiples aplicaciones para la elaboración de alimentos, cosméticos y usos industriales.
Otros aceites alto-oleico con producción importante y buenas características son los de girasol, canola y cártamo; también el de cacahuate, maíz, algodón y soya.
A partir de la primera elaboración de un aceite alto-oleico, los investigadores se dieron prisa para elaborar nuevos aceites y eliminar la hidrogenación para la fabricación de mantecas, margarinas y muchas emulsiones. Se sabe que las grasas de origen natural, incluyendo la leche materna, contiene ácidos grasos trans, al igual que las grasas de origen animal como la leche de vaca, y también algunas de origen vegetal como las margarinas y mantecas vegetales que se fabrican a partir de la hidrogenación de los aceites vegetales líquidos.
Un requerimiento clave de la funcionalidad de las grasas y aceites en una gran variedad de aplicaciones es su estabilidad oxidativa durante la elaboración de frituras y panadería con mayor vida de anaquel. En el pasado, este requerimiento fue cubierto con el uso de grasas y mantecas de origen animal (cerdo, vaca, aves y otros- en inglés, shortening, lard, tallow, etc.). Desde que se demostró que las grasas animales contienen un elevado contenido de colesterol sérico fueron objeto de escrutinio, lo que llevó a los nutricionistas a recomendar la reducción del uso de alimentos ricos en grasas saturadas de origen animal; lo que impulsó la reformulación de aceites y grasas sin colesterol y bajos en grasas saturadas. En década de 1980 bajo la presión de algunas instituciones como el Center of Science in the Public Interest (CSPI) bajo la dirección de Phil Sokolof integrante del National Heart Savers Association (NHSA), con un gran despliegue en los medios de comunicación solicitaron a los restauranteros eliminar el uso de mantecas animales para la elaboración de frituras -en especial papas fritas, carnes y algunos tipos de galletas.
De acuerdo con Mark G. Matloci (En Flider, 2021), la demanda de aceites alto-oleico se ha desarrollado a partir de cambios en la comprensión de las características físicas y químicas de los lípidos dietéticos y cómo alteran la bioquímica del suero, la sustancia más acuosa de la sangre y de la leche.
Durante la década de 1990, la ciencia de la nutrición logró estudios importantes en nutrición como los que hicieran Mensink & Katan publicados en New Journal of Medicine (1990) un artículo con evidencias científicas en donde sostenían la alarma del peligro que representan los ácidos grasos trans en la salud que elevan el colesterol, en especial lipoproteínas de baja densidad (LDL) mientras que no incrementan las lipoproteínas de alta densidad (HDL). Sugerían que el ácidooleico debería ser utilizado ampliamente para reemplazar los ácidos grasos trans de las grasas saturadas y de los aceites parcialmente hidrogenados, como las margarinas.
A finales de la década de 1990, el consenso había convencido a la mayoría de los científicos especializados en nutrición. K Liechtenstein y colaboradores publicaron en 1999 un artículo en New England Journal of Medicine, acerca del efecto de estos productos en la salud humana. Aceites líquidos con niveles elevados en ácido graso linoleico produce una baja de colesterol LDL, mientras que la mantequilla y grasas animales tienen un efecto en el incremento de todos los tipos de colesterol.
Efecto de las grasas trans en el colesterol sérico de los seres humanos
Jacobsen , director ejecutivo de CSPI
for Science in the Public Interest con sede en Estados Unidos y representación en otros países y que asume la responsabilidad de recomendar a los gobiernos, instituciones y consumidores a tener alimentos saludables, sustentables y accesibles para todos, escribió: “Hace veinte años, los científicos (entre los que me incluyo) pensaban que las grasas-trans eran inocuas. Desde entonces, hemos aprendido mucho; se logró la eliminación de ácidos grasos-trans de aceites parcialmente hidrogenados en fritura profunda en los restaurantes, y tomamos en cuenta las nuevas evidencias”. En enero de 2006 la Federal Drug Administration de Estados
Unidos (FDA) solicitó a la industria de alimentos declarar en la etiqueta de contenido nutricional la cantidad de ácidos grasos trans. Esto creó la necesidad de utilizar aceites vegetales con mayor estabilidad, y en ese entonces, a excepción del aceite de oliva y los aceites de girasol alto-oleico (~ 80% oleico), muy pocos otros aceites cumplían con los requisitos de tener altos niveles de ácidos grasos-oleico. Y, aunque no es aceptado por todos, el aceite de palma fraccionado con el que se obtiene oleína también cuenta con niveles altos de ácido-oleico.
Las semillas que contienen cantidades importantes en ácido-oleico (ácidos monoinsaturados omega-9), han ganado atención en los últimos años por su composición en ácidos grasos que proporcionan estabilidad oxidativa y térmica y además presentan un perfil saludable. La guía nutricional de la Organización de las Naciones Unidas para la Agricultura y Alimentación (FAO) recomienda el uso de este tipo de aceite para una alimentación saludable.
Los beneficios para la salud de los aceites alto-oleico en la nutrición humana, son muchos, especialmente por sus propiedades funcionales que requieren varios alimentos, medicamentos, cosméticos y aplicaciones industriales.
La oxidación de los lípidos ha sido reconocida como la reacción predominante en los aceites vegetales, producen cambios que deterioran su composición química, capacidad sensorial, y propiedades nutricionales.

La estabilidad oxidativa del aceite depende de dos factores: la composición de ácidos grasos y la presencia de antioxidantes naturales como los tocoferoles. Aunque las grasas saturadas ofrecen estabilidad oxidativa, su concentración en grandes cantidades, los hace menos deseables para aplicaciones en alimentos; por ejemplo, fritura profunda.
Hibridización de las plantas. – Cruzamiento de plantas hasta tener la variedad más apropiada y rica en ácidos grasos alto-oleico, tal como se hizo con el girasol en sus primeras etapas.
Biotecnología.- En cuando se incrementó la demanda de aceites alto-oleico a finales de la década de 1990, se incrementó la modificación genética de algunas semillas, y ya en el siglo XXI registró un significativo incremento; especialmente en el desarrollo de la soya, cártamo, canola y otros. La biotecnología puede transformar las enzimas de hidrogenasa en las plantas y bloquear la producción de ácidos grasos poliinsaturados, para dejar libres y en altos niveles el ácido graso oleico.
La biotecnología, hasta la fecha, se ha expandido con éxito en muchas regiones del mundo; especialmente, útil en cultivos extensivos, y aunque tiene un buen número de detractores, críticos especialmente al uso de herbicidas resistentes a la planta, esta técnica sigue su curso con nuevas modificaciones y alternativas.
Interesterificación.- Otro uso de los aceites alto-oleico como un componente líquido es la interesterificación para elaborar mantecas y margarinas, que se producen previamente vía la hidrogenación parcial de los aceites líquidos: soya, maíz, o canola. Los niveles de trans como alternativa para reemplazar los ácidos grasos trans, tuvo éxito en Europa en la década de 1990 lo cual permitió regular las grasas trans en la dieta. En los Estados Unidos, algunos tipos de intresterificación química permitió la producción de sustitutos de manteca de cocoa y también algunos tipos de mantecas y margarinas.
Los investigadores también empezaron a utilizar la inmovilización de lipasas para la interesterificación enzimática de las grasas. Aunque, por su alto costo, en un inicio esta
técnica se utilizó únicamente para productos especializados como leches que sustituyen la leche materna y para fórmulas infantiles. Las nuevas enzimas tenían un costo mucho más accesible y ventajas para su procesamiento, como la eliminación del proceso de blanqueo del aceite lo que disminuye las pérdidas de ácidos grasos en aguas residuales.
El aceite líquido convencional se ha utilizado como componente para la elaboración de margarinas que no requieren gran estabilidad oxidativa como es el caso de los aceites para fritura, pero tiene una corta vida de anaquel. Sin embargo, las mantecas vegetales se utilizan en productos que se hornean y requieren vida de anaquel prolongada y, por tanto, gran estabilidad.
Por ejemplo, las galletas, pueden elaborarse con mantecas interesterificadas que son equivalentes a las que se producen con aceites parcialmente hidrogenados; aunque después de seis meses en el anaquel, empiezan a desarrollar aromas desagradables debido a la disminución de la estabilidad oxidativa. Sin embargo, cuando la interesterificación se utiliza en aceites alto-oleico, las mantecas y margarinas tienen una gran estabilidad igual o parcialmente a las mantecas parcialmente hidrogenadas y por tanto, los productos tienen una larga vida de anaquel.
Los aceites alto-oleico. Cuando las mantecas se interesterifican tienen otros beneficios. Presentan gran estabilidad de resistencia a la oxidación. También presentan bajas cantidades de ácidos grasos saturados y buenas cualidades nutricionales.
Biología sintética.- Actualmente, la biotecnología desarrolla nuevas herramientas y aplicaciones moleculares a una velocidad vertiginosa. Tales desarrollos están orientados a la modificación genética de organismos, o al diseño y la generación de nuevos organismos (no naturales) y productos biotecnológicos de interés comercial (biología sintética). Los nuevos desarrollos biotecnológicos implican posibles beneficios y posibles efectos adversos en la conservación de la diversidad biológica, así como el uso sustentable de los mismos, que hay que evaluar paso a paso (Cibiogem - Conacyt, México, 2022).
Biología molecular.- Avances importantes en biología molecular están modificando las técnicas para crear cambios muy eficientes y específicos (por ejemplo, nucleótidos simples) en los genes que influyen en la ruta metabólica con la utilización
de microbios en la producción de aceites (almidón y algas) y plantas. Las técnicas de edición genómica como el TALEN y CRISPR tienen la capacidad de silenciar los genes que pueden mejorar la producción de aceites con una composición única de triacilgliceroles, incluyendo aceites alto-oleico. La selección con asistencia de marcadores específicos (MAS) así como inducción centralizada para localizar genomas específicos (TILLING)
está llegando a mejorar la comercialización de pruebas en cultivos que tradicionalmente se han realizado con prácticas de cultivo tradicionales. Las nuevas técnicas con biología molecular están siendo muy eficaces y son de gran ayuda para la comercialización de cultivos alto-oleico. (Flider, 2021)
alto-oleico y del aceite de aguacate
naturalmente alto-oleico: dos plantas de origen mexicano.
Aceite de girasol alto-oleico
La historia del girasol (Heliantus annus) es sorprendente. Planta originaria del norte de México y sur de Estados Unidos cuyo cultivo se practica desde hace más de 3,000 años. En el siglo XVI, los españoles lo llevaron a Europa con fines ornamentales y medicinales. En 1716 empezó la fabricación de aceite con semilla de girasol; sin embargo, el gran incremento en su cultivo y comercialización del aceite inició en 1830 en Rusia y Ucrania, hasta la fecha, países de gran producción de aceite de girasol.
De acuerdo con datos de International Sunflower Association.
History of Sunflower Breeding in the World. En la década de 1970, gracias a los avances en el análisis de los compuestos químicos y características físicas de los aceites, en Rusia, investigadores empezaron a considerar que un aceite óptimo para la salud debía tener un elevado contenido de ácido-oleico, semejante al de oliva. El investigador soviético Karm Ivanovich Soldatov trabajó en la mutación química de las semillas de girasol para conseguir inactivar el gen de la FAD-2 y dejaba que crecieran las plantas. Una vez florecidas, recogía las semillas y analizaba su contenido de ácido-oleico; entonces, cruzaba las plantas y repetía el proceso, logrando de esta manera, semillas cada vez más ricas en ácido-oleico y con un contenido bajo en ácido linoleico.
Siguiendo este procedimiento, a partir de semillas de girasol Núm-8931, desarrolladas en el Instituto Pustovoit de
La fruta del aguacate se consume en su forma natural y en la preparación de algunos platillos, entre los que sobresale el guacamole, fruto rico en ácidos grasos monoinsaturados, ácido oleico, y ácido palmitoleico así como buen contenido en lípidos antioxidantes solubles, fitoquímicos y proteínas, muy nutritivas y muy importantes para la salud humana.

Investigación de Cultivos Oleaginosos (VNIMK), e 1971 Soldatov consiguió una variedad de semilla de girasol con un 60% de ácido-oleico. Presentó estos resultados en el Séptimo Congreso Internacional del Girasol, que tuvo lugar en Krasnodar URSS en 1976, pero nunca patentó sus investigaciones, sin que las causas, hasta la fecha, estén resueltas.
La patente de girasol alto-oleico la obtuvo Gerhardt N. Fick, funcionario de la empresa Seed America Inc., de Estados Unidos. Por vez primera Fick patentó un girasol alto-oleico obtenido a partir de la variedad Pervenets en 1985 y el aceite de girasol alto-oleico en 1988.
El aguacate (Persea americana) es un fruto originario de tierras templadas de México con altos niveles de aceite monoinsaturado y es un recurso excelente por sus compuestos de lípidossolubles como tocoferoles, carotenoides, y fitoesteroles, que juegan un papel muy importante en la reducción de riesgos de padecer enfermedades cardiovasculares y con otros buenos beneficios para la salud.
Valor nutricional por 100g de materia prima de aguacate ‘Hass’*
Energía 670 kj (160 kcal)
Carbohidratos 8,53 g
Azúcares 0.66 g
Fibra dietética 6.7 g
Grasas 14.66 g
Saturadas 2.13 g
Monoinsaturadas 9.80
*Los porcentajes representan cantidades aproximadas utilizando las recomendaciones de Estados Unidos para adultos. - Departamento de Agricultura de Estados Unidos. A. R. S. (2019) / Flider J. Frank. High Oleic Oils (2021).
Las características del aceite de aguacate son comparables a las del aceite de oliva en cuando a su alto contenido de grasas monoinsaturadas, micronutrientes funcionales (β-sitoesterol), y vitaminas con lo cual es un aceite muy adecuado para la cocina. El contenido insaponificable de este aceite procedente de frutos inmaduros oscila entre el 15%-40% en comparación con el aceite que se obtiene de frutos maduros 4%-9%. Por sus propiedades deseables, la fracción insaponificable del aceite es muy apreciada en la industria farmacéutica y para cosméticos, especialmente cremas para suavizar la piel.
La variedad de aguacate Hass, la más común y abundante hasta la fecha, tiene un alto contenido de ácidos grasos monoinsaturados, sabor característico y alto punto e humeo (±250°C o 482°F), muy apropiado para frituras. El aceite de aguacate variedad Hass prensado en frío es verde brillante, color que se atribuye a los altos niveles de clorofila y carotenos. Se ha descrito que su sabor es semejante a una grasa suave propia de algunos hongos.
Propiedades: Contiene 3.6 mg de vitamina E de β-sitoesterol y es bajo en acidez, lo cual ayuda a incrementar su punto de humeo. Bajo el proceso de interesterificación (química y enzimática) se solidifica y se puede utilizar para cocinar, hornear, freír, fritura profunda, salsas, asado, rostizados, cremas para untar, emulsiones, aceite para ensaladas, condimentos y muchos otros procesos y productos comestibles. ´
Ácidos grasos saturados: 11.6 Ácidos grasos monoinsaturados totales: 70.6 – oleico Omega-9: 52%-66% Ácidos grasos poliinsaturados: total: 13.5%; -linolénico: 1; linoleico: 12.5%.
En fechas recientes Luckas J. Stolp y Dharma R. Kodaly investigadores en la Universidad de Minnesota, demostraron que el ácido palmitoleico es una sustancia (del grupo) benéfica para la salud con diferentes efectos como tener propiedades anti-inflamatorias, ayuda a reducir el peso corporal, reduce los niveles de glucosa sanguínea y de triglicéridos, además mejora el perfil de insulina. El aceite de oliva contiene bajo contenido de ácido palmitoleico (0.3%-3.5%), mientras que el aceite de aguacate contiene cantidades moderadas (4%13%), pero el aceite de nueces de macadamia es un excelente recurso de ácido palmitoleico (17%-20%). Además de una gran concentración de monoinsaturados, el principal recurso para mantener la salud, buena nutrición y propiedades farmacológicas de estos aceites que proceden de bajas cantidades de componentes que constituyen los fitoesteroles, tocoferoles, fenoles, escualenos, carotenoides y otros.
Tal como muchos países en el mundo han seguido el camino de la búsqueda de aceites más saludables, con procedimientos más eficaces desde la producción de semillas, hasta nuevas
Los aceites alto-oleico proporcionan estabilidad oxidativa y térmica, especialmente los naturales como oliva o aguacate, porque conservan su sabor y aroma típicos, y con pan o jocoque resultan ser deliciosos.
formulaciones. De todos los aceites, los más saludables y con mayor demanda son los aceites alto-oleico, ya sean de origen natural o procesados.
El suministro de aceites alto-oleico aumentará en los próximos años, especialmente de semillas de alto consumo; la soya y la canola, así como aceites alto-oleico procesados con algas marinas en grandes volúmenes y a precios razonables, los que, por su estabilidad oxidativa, serán objeto de estudio para el desarrollo de nuevos alimentos más saludables y perfil más nutritivo.

International Sunflower Association. Estados Unidos. 2022. CONABIO / CONACYT. México, 2022
Flider J. Frank (editor). High Oleic Oils: Development, Properties, and Uses (primera edición 2021).
Jacobsen, Michael. CSPI (Center for Science in the Public Interest, USA. 2021.


La reducción de los 3-monocloropropano-1,2-ésteres-diol (3-MCPDEs por sus siglas en inglés) y ésteres-glicidil (GEs por sus siglas en inglés), son sustancias contaminantes -consideradas antinutrientes- que deben ser removidas con procedimientos y estrategias adecuadas y cuidadosas. Deben iniciar desde el cultivo, cosecha, transporte y almacenaje de los frutos y semillas oleaginosas, y seguir durante todas las etapas del proceso de refinación y post-refinación con atención de las temperaturas y detección de ciertos compuestos clorinados, tal como lo reporta la investigadora Serena Lim* en el artículo “3-MCPDE&GE: Mitigation Strategies” publicado en Oils and Fats International de Julio/Agosto de 2019, con datos del Código de Prácticas (CoP) emitido por el Codex Alimentarius Commission de las Naciones Unidas a principio del 2019.

Los aceites comestibles vegetales se producen con varios frutos, semillas, nueces y, también se procesan aceites de pescado. Es común que ambos tipos de aceite sean refinados a temperaturas de 200°C -o mayores- lo cual puede producir sustancias contaminantes -antinutrientres que se sospechason carcinogénicas.
Los seres humanos estamos expuestos los contaminantes 3-MCPDEs y GEs a partir del consumo de aceites comestibles refinados o alimentos que se han preparado con este tipo de aceite, y también pueden encontrarse en fórmulas infantiles, suplementos dietéticos, productos fritos y alimentos horneados.
La presencia de 3-MCPDE y GEs en aceites comestibles fue reportado por vez primera a mediados de la década del 2000 y desde entonces se llevado a cabo muchos estudios y se han emitido varias regulaciones y recomendaciones, que determinan los límites máximos y mínimos de estos contaminantes.
En la Unión Europea los niveles máximos para los GEs se establecieron en febrero de 2018, mientras que la European Food Safety Authority (EFSA) sugiere una ingesta diaria tolerable para los 3-MCPEs en enero de 2018 de 2mg/kg del peso corporal diarios (0.002ppm/kg diarios).
El Codex Alimentarius Commission (CAC) de las Naciones Unidas, desde 2019 establece un Código o Práctica (CoP) y la forma como prevenir o reducir la formación de 3-MCPDE y GE en los aceites refinados y alimentos que se elaboran con aceites refinados.
EFSA (European Food Safety Authority), ha encontrado que el aceite de palma y grasas derivadas del aceite de palma poseen importantes niveles de 2-MCPD, 3-MCPD (incluyendo ésteres) y GE semejante a los otros aceites vegetales.
En aceites sin refinar no se ha detectado la presencia de 3-MCPDE o GE, aunque tienen diferentes capacidades para
formar estas sustancias durante la refinación, de acuerdo con el (CAC) Codex Alimentarius Commission y (CoP) Código o Práctica emitido por esta institución.
Las condiciones durante el proceso de refinación también tienen un importante efecto en la formación de 3-MCPDE y GE.
Las prácticas agrícolas influyen en las semillas para la formación de 3-MCPDE y GE, mismas que hay que eliminar durante la refinación del aceite. (ShutterStock)

“Para los aceites vegetales, los factores agrícolas que contribuyen a aumentar la capacidad de formar 3-MCPDE y GE durante la refinación incluyen las condiciones del clima, suelo, y desarrollo de las plantas o árboles, su genotipo y las técnicas de cosecha. Estos fatores afectan los niveles de 3-MCPDE y GE, como son los acil-gliceroles y compuestos clorinados”, señaló el equipo del CoP.
“El 3-MCPDE se forma principalmente con la reacción entre los compuestos que contienen cloro y acilgliceroles como son los tri-acil-gliceroles (TAGs), di-acilgliceroles (DAGs) y mono-acil-gliceroles (MAGs)”. Los GE se forman principalmente de los DAGs y MAGs.
Algunos compuestos clorinados también son precursores de la formación de 3-MCPDE. Las fábricas procesadoras de aceite con semillas y granos, absorben iones de cloro (en forma de compuestos clorinados y de agua. Estos iones clorinados se convierten en compuestos clorinados reactivos, promoviendo la formación de
3-MCPDE durante la refinación, señaló el equipo CoP.
Los frutos que se utilizan para la refinación de aceites contienen la enzima lipasa. La actividad de la lipasa se incrementa cuando la fruta está madura, mientras que la actividad de la lipasa en semillas permanece estable. La lipasa interactúa con el aceite procedente de frutos oleaginosos que rápidamente se degradan en TAG dentro de los ácidos grasos libres (FFAs Free Fatty Acids), DAGs y MAGs). El efecto de la lipasa en las semillas que han sido apropiadamente almacenadas es negativo.
En vista que estos contaminantes se forman vía diferentes mecanismos, las estrategias para eliminarlos también son diferentes y necesitan del control de los 3-MCPDE porque se forman directamente asociados con temperaturas elevadas, que inician en 200°C y continúan en forma más significativa con temperaturas superiores a los 230°C, señaló el equipo de CoP.
Los GE se forman principalmente de los DAGs y no requieren de la presencia de compuestos clorinados. Los aceites pueden ser deodorizados a temperaturas inferiores a los 230°C para evitar una formación significativa de GE. Sim embargo, este no es un procedimiento práctico porque hay que disminuir las temperaturas de la deodorización lo cual requiere establecer el umbral adecuado para evitar la formación de 3-MCPDE (160200°C), y de no ajustar adecuadamente la temperatura compromete la calidad y seguridad del aceite.
La cosecha y cuidado de los frutos de palma deben procesarse lo más rápido posible a fin de evitar condiciones que propician la formación de 3-MCPDE Y GE
El equipo CoP señala que aunque los 3-MCPDE y GE se producen principalmente durante la deodorización, las medidas de control pueden aplicarse a lo largo de la producción del aceite comestible, iniciando con buenas prácticas agrícolas (sistema de cultivo, cosecha, transporte y almacenamiento de los frutos y semillas), que pueden eliminar estos contaminantes durante la refinación (producción de aceite crudo y su tratamiento, desgomado/blanqueo y deodorización), así como el proceso de post-refinación con medidas tradicionales (blanqueo y deodorización adicionales, además del uso de tierras de blanqueo).
“En lo posible, uno de los precursores más eficientes para eliminar los precursores en las primeras etapas del procesamiento, es minimizar la formación de 3-MCPDE y GE.
“En concreto a partir de la reducción de los 3-MCPDE y GE es también importante considerar los efectos en la calidad de los aceites refinados y los productos que se elaboran con aceites
refinados, incluyendo propiedades como las olfativas y de sabor, estabilidad, niveles de nutrientes, y la eliminación de contaminantes como pesticidas y micotoxinas”.
La producción de aceites vegetales comestibles implica varias etapas principales: cultivo, cosecha, transporte y almacenamiento de frutos y semillas y también frutos de palma de aceite que se utilizarán, los que requieren de un proceso de esterilización y extracción del aceite crudo: molienda de semillas con limpieza de las semillas, uso de vapor, extracción del aceite crudo y refinación del aceite crudo.
Existen dos principales tipos de refinación de aceites vegetales. La refinación química que consiste en el desgomado (eliminación de fosfolípidos); neutralización (adición de una solución de hidróxido para eliminar los ácidos grasos libres -FFAs- precursoras de la formación de jabones); blanqueo (utilizando arcillas) para reducir el

color y eliminar los remanentes de jabón, y gomas, trazas de metales, y productos de degradación; y la deodorización (con procesos de destilación con vapor que se lleva a cabo con presión baja, 1.5-6.0 mbar, y temperaturas elevadas 180-270°C) para eliminar los ácidos grasos libres, colores, y compuestos volátiles, incluyendo algunos contaminantes.
La refinación física implica el desgomado, el blanqueo y la deodorización (que tiene lugar a temperaturas más altas que las que se utilizan en la refinación química), porque no se lleva a cabo el paso de neutralización. Mientras que algunos factores influyen en la selección de la refinación física, típicamente se lleva a cabo en aceites que contienen niveles bajos de fosfolípidos.
El equipo del CoP señala que cuando este procedimiento se lleva a cabo con el fruto de árboles nuevos de la palma de aceite, los palmicultores deben seleccionar las variedades de plantas con baja actividad de lipasa en el aceite de los frutos, porque la baja actividad de la lipasa es un factor que puede reducir la formación de ácidos grasos libres (FFA) y precursores de acil-glicerol.
“Durante el cultivo de plantas o árboles oleaginosos, los agricultores deben minimizar el uso de sustancias como fertilizantes, pesticidas y agua que tenga excesivos niveles de compuestos clorinados, a fin de reducir la absorción de las plantas y semillas de estos compuestos. Es importante utilizar fertilizantes no-clorinados que pueden ser una alternativa para el uso de fertilizantes que contienen clorinados”.
Los agricultores deben cosechar los frutos de la palma de aceite cuando están en su madurez óptima, minimizar la manipulación de los frutos para prevenir la formación de ácidos grasos libres (FFA) y evitar el uso de frutos dañados o demasiado maduros, que pueden estar asociados con la formación de altos niveles de 3-MCPDE y GE. Los frutos de palma de aceite deben ser transportados hacia las plantas de procesamiento lo más rápido posible.
Lim señala que el plan de CoP para los frutos de palma en la fábrica de molienda, recomienda que los procesadores deberán
esterilizar el fruto inmediatamente (de preferencia) con menos de dos días después de la cosecha a temperaturas menores a los 140°C para inactivar las lipasas (con temperaturas que varían de acuerdo al método de esterilización) para remover los precursores clorinados. Para las semillas, los procesadores deberán limpiar, moler y calentar para inactivar las lipasas.
“Los procesadores deberán considerar lavar el aceite vegetal crudo con agua libre de cloro a fin de remover el contenido de compuestos de cloro. Deberán eliminar el uso de aceite vegetal residual recuperado después del uso de solventes o extracciones adicionales, porque este aceite tiende a tener altos niveles de precursores, como DAGs y compuestos que contienen cloro.
Los procesadores deberán también medir los precursores en los contenedores de aceite vegetal crudo o aceite de pescado (como los DAGs, FFAs o compuestos que contengan compuestos de cloro) para ajustar los parámetros de la refinación o marcar la estrategia más apropiada de mitigación dependiendo del tipo de aceite vegetal o aceite de pescado que será procesado, así como también las condiciones para el procesamiento.
“Es preferible que la refinación del aceite vegetal crudo o el aceite de pescado con bajas concentraciones de precursores puedan producir aceites terminados con niveles bajos de 3-MCPDE y GE.
Desgomado: Durante la etapa del desgomado, los procesadores deberán utilizar menos condiciones que propicien la acidez (un desgomado con baja concentración de ácido fosfórico, cítrico o cualquier otro tipo de ácido o agua para desgomado) y que ayuden a disminuir los niveles de 3-MCPDE en los aceites vegetales y en los aceites de pescado. La concentración de ácido depende de la calidad del aceite vegetal crudo o del aceite de pescado que se trate. El cuidado deberá usarse para remover concentraciones suficientes de fosfolípidos y de ácidos grasos libres, con el objetivo de garantizar una mejor calidad.
Al bajar la temperatura durante el desgomado se disminuye la formación de precursores de 3-MCPDE en aceites vegetales. Sin embargo, la temperatura del desgomado dependerá de numerosos factores que incluyen el tipo de aceite vegetal que se está procesando.
Neutralización: Al utilizar químicos para la refinación (neutralizadores) como una alternativa a la refinación física, es una medida que puede ayudar a remover los precursores (como el cloro) para reducir los FFAs y tener la posibilidad de bajar la temperatura de la deodorización en aceites vegetales y aceites de pescado. Sin embargo, la refinación química puede ser causa de una excesiva pérdida de aceites (especialmente para la palma de aceite debido a niveles altos de FFA) y puede tener un grave impacto en el medio ambiente mayor al de la refinación física.
Blanqueo: El uso de cantidades importantes de arcillas de blanqueo puede reducir la formación de 3-MCPDE y GE en aceites vegetales y en aceites de pescado. Sin embargo, las arcillas de blanqueo que contienen cantidades significativas de compuestos de cloro deberán ser rechazados.
aceites vegetales y menor a 190°C en aceites de pescado. La temperatura podrá variar de acuerdo con el tipo de tiempo de exposición del aceite.
Como alternativa a la deodorización tradicional, los procesadores pueden controlar tanto la deodorización de aceites vegetales como la de aceites de pescado (2 etapas de deodorización) para disminuir la carga final de aceite y reducir la formación de GE, y una pequeña reducción de 3-MCPDE. Este procedimiento incluye el periodo de la deodorizacion corta con una temperatura mayor y alargar el periodo e deodorización con una temperatura más baja.
“Esta consideración necesita contar con parámetros bien definidos; como es la temperatura, presión del equipo de vacío, tiempo y variaciones del equipo que se esté utilizado y capacidad de aceite. El post-procesamiento requiere reducir los niveles de GE”.
El uso de un sistema de vacío más eficiente puede ayudar a evaporar los compuestos volátiles debido a que se incrementa el volumen de vapor y se reducen los GE, y tener una reducción importante de los 3-MCPDE en comparación con el sistema de deodorización convencional.
El aceite de pescado también deberá ser refinado de acuerdo con las recomendaciones del CoP del Codex Alimentarius a fin de obtener la mejor calidad y eliminar los 3-MCPDE y GE.

El uso de arcillas con pH-neutro reduce la acidez y el potencial para formar 3-MCPDE en aceite de palma, y en algunos tipos de semillas de aceites vegetales y de aceites de pescado.
Deodorización: El dictamen de CoP señala que los procesadores deberán considerar la deodorización de los aceites vegetales y los aceites de pescado a temperaturas bajas para reducir la formación de GE. Por ejemplo, se ha sugerido que la deodorización puede ser aplicada a 190-230°C en los
La ruta corta de destilación mejora la eliminación de compuestos volátiles con temperaturas relativamente bajas. Este procedimiento se complementa a partir de la reducción y control de la presión, debido a la corta distancia que existe entre la superficie de evaporación y de condensación.
Sin embargo, se necesita un post-procesamiento con una deodorización suave a fin de conservar factores sensoriales después de aplicar la ruta corta durante la destilación.
Un blanqueo y deodorización adicional seguido de un blanqueo y deodorización inicial se ha utilizado para lograr niveles bajos de GE en aceite de palma refinado (La segunda deodorización debe llevarse a cabo con bajas temperaturas en comparación con la primera deodorización).
La aplicación o activación de las tierras de blanqueo durante la post-refinación ha mostrado ser eficaz para reducir el GE en aceites refinados.
El uso de la ruta corta en la destilación (a <1mbar en la presión y una temperatura de 120-270°C) en las etapas de blanqueo y deodorización de aceites vegetales puede reducir los componentes de acil-glicerol y los niveles de 3-MCPDE y GE. El tratamiento de refinación con cadenas medias de triacilglicerol (MCT) con ácidos grasos y metales de álcali, así como una o más bases, convierte los 3-MCPDE en MAGs, DAGs, TAGs, y los GE en DAGs.
Es importante la selección del aceite vegetal y del aceite de pescado con bajos niveles de 3MCPDE y GE (ya sea a partir de un procedimiento natural o a partir de una aplicación o mitigación de los niveles), así como la selección de una o más bases, da como resultado que los productos terminados tengan también 3-MCPDE y GE.
Por ejemplo, la variación en los niveles de 3-MCPDE y GE en fórmulas para infantes ha sido observada en una selección de
aceites bajos en 3-MCPDE y GE y que al aplicarse se obtienen alimentos para infantes con bajos niveles en 3-MCPDE y GE.
No obstante, los productores también tienen que considerar la calidad o los factores que integran la composición. Por ejemplo, en fórmulas para infantes, los aceites refinados tienen que ser seleccionados con cuidado para tener la certeza que estos productos tienen la composición requerida.
La reducción de las cantidades de aceites vegetales y aceite de pescado que se utilizan en productos terminados puede ser una alternativa para reducir los niveles de 3-MCPDE y GE en estos productos. Aunque también es posible que se afecten las características organolépticas de los productos terminados. El uso de aceites vegetales refinados durante el freído, por sí mismos no contribuyen a la formación adicional de 3-MCPDE y GE, pero la formación adicional de 3-MCPDE durante el procesamiento de frituras puede resultar de acuerdo con el tipo de alimentos que se están friendo, como son las carnes y los pescados.
*Serena Lim. Investigadora. Editora de Olis and Fats International. Redhill, England. “3-MC´DE & GE: Mitigation Strategies”. Oils and Fats International. July/August 2019.
Asociación Nacional
Industriales de Aceites y Mantecas Comestibles, A.C. ANIAME

Praga 39 – Piso 3
Juárez C.P.06600
de México
Imagen de un conjunto de lípidos bioactivos obtenida en el Instituto de Biología y Genética Molecular. Valladolid, España. 2020.

Avanza rápidamente este innovador campo de la biología enfocada en el estudio de los lípidos celulares, así como al análisis del metabolismo de los lípidos como señalizadores de las células humanas con lo cual ha mejorado el desarrollo de la ciencia básica, la comprensión, diagnóstico y tratamiento de padecimientos metabólicos
D urante los primeros años de este siglo XXI se da un gran impulso a la investigación de la genómica (secuenciación del genoma humano), la proteómica y la metabolómica, con lo cual surge la lipidómica, rama de la biología enfocada al estudio de los lípidos celulares y sus interacciones con otros lípidos, proteínas y metabolitos.
La lipidómica (lipidología) es el estudio en gran escala de las especies lipídicas existentes, así como las vías y redes
metabólicas con las que están relacionadas. El avance de este campo, de acuerdo con Juan Carlos Gómez, se ha hecho posible gracias a las técnicas analíticas como la espectroscopía de masas (MS), conocida como nano-ESI-MS/MS, la ionización por electropulverización, la resonancia magnética nuclear, la espectroscopía de fluorescencia y también por los espectaculares avances en bioinformática.
Al estudiar el metabolismo de los lípidos y la señalización en las células humanas, los investigadores descubren aspectos importantes de las enfermedades humanas como el cáncer, las enfermedades cardiovasculares, los trastornos neurológicos y la diabetes que a su vez, conducirán a nuevos diagnósticos, terapias y tratamientos.
A medida que los científicos utilizan la lipidómica para examinar los miles de moléculas que componen el lipidoma, se están dando cuenta cada vez más que los lípidos hacen mucho más que solo servir como fuente de energía o barrera celular para las proteínas. De acuerdo con artículo publicado en Inform (Mayo 2020) por Rebecca Guenard, Editora Asociada de Inform- AOCS, señala que Anne-Claude Gavin, profesora de bioquímica en la Universidad de Ginebra, dice que: “Ahora, nos hemos dado cuanta que los lípidos y su gran diversidad química es muy importante para organizar la función celular. Los lípidos se componen de un número de bloques de construcción químicos simples, pero tienen el potencial de generar más de cien mil especies moleculares diferentes”.
Gavin prosigue: “Los lípidos son más difíciles de estudiar que las proteínas, porque tienen un código genético que proporciona instrucciones sobre cómo deben funcionar las moléculas”, en consecuencia, desde hace un poco más de diez años, los investigadores ya pueden separar los lípidos que cumplen funciones biológicas críticas, identificando sus funciones y desarrollando productos específicos para el tratamiento de enfermedades metabólicas.
Los lípidos nutricionales.- De acuerdo con Gavin, es posible separar los lípidos biológicos de los nutricionales, de tal manera que, en los próximos años será un tema relevante en la lipidómica.
Los lípidos biológicos-celulares.- representan una amplia gama de compuestos involucrados en diversas funciones celulares. Los lípidos comprenden las membranas de una célula y dirigen el tráfico de la membrana. Las proteínas se adhieren a una superficie de la membrana o transitan en su interior, pero sus tareas dependen de la composición lipídica.
Gran parte del enfoque actual de lipidómica está en comprender cómo se clasifican y distribuyen los lípidos después de la síntesis. Los esteroles y esfinogolípidos, por ejemplo, que se concentran en la superficie de la célula, aunque se forman en su interior son portadores de proteínas y cumplen con diversas funciones.
Los científicos pasaron más de treinta años centrando sus experimentos de biología molecular en el ADN, ARN y en
las proteínas. En la última década la investigación de lípidos ha ganado más atención. Ahora, los lípidos biológicos están siendo el centro de atención como soluciones potenciales a los desafíos médicos, nutricionales, terapéuticos y cosméticos. A medida que los científicos utilizan la lipidómica para examinar los miles de moléculas que componen el lipidoma, se están dando cuenta de que los lípidos hacen mucho más que servir como fuente de energía celular y ser transportadores de proteínas.
“Los lípidos se acumulan en áreas muy especiales de los sistemas celulares. Esto es absolutamente clave para la biología celular” -dice Gavin- y generan la organización celular; aunque los investigadores aún no saben exactamente cómo se crean y mantienen estos procesos. En el pasado, se creía que las proteínas eran las únicas sustancias operadoras en el transporte, pero cada vez está más claro que trabajan al unísono con los lípidos para realizar esta tarea. Gavin y sus colaboradores mapean las rutas lipídicas para comprender los esquemas de transporte: “Podemos medir los lípidos dentro de la célula y seguir su destino metabólico”, señala.
En su artículo, Guenard apunta que, como ha indicado Besim Ogretmen, profesor de bioquímica en la Universidad Médica de Carolina del Sur, en Charleston, USA, “Hace veinte años, era realmente difícil trabajar con lípidos biológicos. Dependíamos principalmente de análogos de moléculas lipídicas”. Los investigadores en lipidómica ahora combinan la química orgánica y analítica con la genética. “Entonces, en lugar de mirar los análogos de lípidos, en realidad podemos cambiar la síntesis en las células”, dice Ogretmen.
De acuerdo con Stephen Stein, director del Grupo de Centros de Datos de Espectrometría de Masas, “Desde hace quince años, en colaboración con su colega y líder del proyecto Xiaoyu Yang, han formado una biblioteca espectral de masas que ahora contiene 3.3 millones de entradas para más de 30,000 compuestos, incluidos varios lípidos como esteroides, fosfolípidos y goicolípidos. Los estándares se han recogido de lípidos disponibles comercialmente, así como metabolitos de muestras humanas”.
La resolución aún no es subcelular, pero está cada vez más cerca -señala Stein-. Los científicos pronto podrán obtener información sobre la dinámica de los lípidos, como la disposición de los grupos de una especie de lípidos que encabezan otra serie de lípidos con diferentes funcionamientos dentro de las membranas celulares. La comprensión de las complejidades de los lípidos a nivel celular ha preparado el campo para una avalancha de nuevos estudios centrados en la salud y la nutrición.
afecta la composición de estos compuestos en las membranas celulares. Hasta ahora, los investigadores han estudiado las clases de lípidos más comunes, como los triacilglicéridos, el colesterol, los ésteres de colesterol, los glicerofosfolípidos y las ceramidas.
Una variedad de estudios centra su interés para entender el impacto de los diferentes tipos de lípidos. Han encontrado que los esfingolípidos, que se encuentran en las membranas celulares, juegan un papel importante en el desarrollo de varios padecimientos y, de esta manera es posible diseñar sus terapias; por ejemplo, para ciertos tipos de cáncer, la enfermedad de Alzheimer, la inmunoterapia y el envejecimiento.
El perfil de la composición molecular de lipidoma plasmático sugiere que algunas clases de lípidos relativamente poco abundantes pueden estar involucrados en trastornos relacionados con la dieta. Para saberlo con certeza, Gavin dice que es tiempo de armar el equivalente a un código genético para los lípidos. “Es absolutamente crítico ahora que tenemos una lista completa de todos los lípidos del cuerpo, con lo cual realmente empezamos a compilar el lipidoma humano”, señala Gavin.
Construir la base de conocimiento de lipidómica para comenzar a responder preguntas sobre la salud y la enfermedad humanas -señala Guenard- ha sido un proceso lento. Pero ahora que se están compilando datos y se reúnen en bibliotecas especializadas y se establecen las herramientas analíticas, los investigadores están listos para utilizar lo que han aprendido.
“Realmente hemos luchado para comprender estas moléculas de lípidos para identificar las enzimas, sus sitios metabólicos y cómo se regulan”, dice Ogretmen. “Ahora que tenemos todas estas herramientas, las personas comenzarán a hacer esas preguntas importantes sobre la dieta y los factores ambientales que afectan el metabolismo y la señalización de los lípidos.
Por ejemplo, desde hace unos años, está comprobado que una dieta rica en ácidos grasos omega-3 tiene el beneficio conocido de reducir las enfermedades cardiovasculares; sin embargo, se sabe poco acerca de cómo el contenido de lípidos de la dieta
Según anuncia Begoña Ochoa , investigadora del Departamento de Fisiología de la Facultad de Medicina y Odontología. UPV/EHU. Leioa. Bizkaia. España: “En el reciente Congreso de la prestigiosa Sociedad Europea de Bioquímica y Biología Molecular, FEBS ‘New Concepts in Lipidoogy: from Lipidomics to Disease’ se ha presentado la creación de una iniciativa europea en lipidómia, la “European Lipidomics Initiative” (www.lipidomics.net). Esta iniciativa pretende definir estrategias de investigación empleando la lipidómica como técnica y crear una plataforma de expertos en lipidómica ‘Lipidomics Expertise Platform’ (www.lipodomics-expertise.de), así como construir una red de conocimiento con la genómica y proteómica, las otras dos aproximaciones basadas en la biología de sistemas al estudio de la enfermedad más asentadas”.
Referencias: Gómez, Juan Carmelo. Lipidómica (2022). Periódico La Verdad. Murcia. España. Guenard, Rebecca. Lipidomics: comes of age (2020). Inform Magazine. International News on Fats, Oils, and Related Materials. AOCS. Vol. 31. May. Ochoa, Begoña. La lipidómica, una nueva herramienta al servicio de la salud (2022). Departamento de Fisiología. Facultad de Medicina y Odontología. Bizkaia. España.



El biodiesel o éter metílico de ácidos grasos, es un combustible alternativo al diesel, de origen natural; es obtenido de la reacción de aceites vegetales y grasas animales con un alcohol liviano, principalmente alcohol metílico. Este proceso inicia con la extracción de aceite de semillas oleaginosas como girasol, canola, semilla de soja, aceite de palma, entre otros. Por otro lado, el biodiesel también se puede producir mediante el reciclaje de aceites y grasas usadas.
El diesel (gasóleo) hidrocarburo liquido de densidad sobre 850kg/m3, compuesto fundamentalmente por parafinas, utilizado como combustible en calefacción y motores diesel (wikipedia). El diesel funcionó por primera vez en Alemania en 1893.
Cada año desde 1893, el 10 de agosto se celebra el día internacional del biodiesel, en conmemoración al ingeniero alemán Rudolf Christian Karl Diesel, quien diseñó y puso en marcha el primer motor que utilizó aceite de cacahuate como combustible. Su objetivo fue desarrollar un motor de combustión interna alternativo a las maquinas de vapor que eran muy pesadas y costosas, lo que ya las hacía poco eficientes; que posteriormente fue un motor biodiesel. En 1892 obtuvo la patente de su invención, y en 1893 publicó una descripción de su mecanismo teórico y práctico en el libro “Teoría y Construcción de un motor térmico racional para sustituir la máquina de vapor y los motores de combustión interna conocidos hasta la fecha”, donde
Rudolf Diesel. Ingeniero alemán y francés, inventor del carburante diesel y del motor de combustión de alto rendimiento que lleva su nombre, el motor diesel, (1858-1913).
expuso sus ideas de construir un motor que funcionara de acuerdo al ciclo de combustión interna inventado por Nikolaus Otto –ingeniero alemán reconocido mundialmente por haber creado el primer motor de gasolina, con carga comprimida, en 1876- y el uso de la mezcla aire/combustible, reduciendo los costos de operación.
En 1897, la empresa Maschinenfabrik Augsburg-Nürnberg (MAN), que apoyó a Rudolph Diesel en su proyecto, presentó el primer motor de diesel de cuatro tiempos, el cual podía desarrollar una potencia de 25 caballos de vapor. En 1900, durante la gran Exposición Universal en Paris, Rudolf Diesel presentó frente a millones de personas, un motor que funcionaba mediante aceite de cacahuate como combustible. Debido al énfasis del ingeniero Diesel en
emplear materiales biológicos, es que se conmemora como día internacional del biodiesel.
“El motor diesel puede ser alimentado con aceites vegetales y podrá ayudar considerablemente al desarrollo de la agricultura en cada país. Este parece un sueño de futuro, pero no puedo predecir con entera convicción que este modo de empleo del motor diesel, puede, en un tiempo dado adquirir una gran importancia”. (Rudolf Diesel, 1879)
Actualmente, la producción de biodiesel suele realizarse mediante aceites y grasas recicladas, para ayudar a reducir los impactos en el medio ambiente, mismas que resultan una materia prima más barata. Sin embargo,
en diversas regiones del mundo se produce el biodiesel directamente de las oleaginosas, por ejemplo, en la región del Norte de América, África y Sur de América, la producción de dicho combustible se basa principalmente en el aceite de soja; en Centro América se emplea aceite de palma, mismo que sucede en Malasia, Indonesia y países cercanos a la región. En el Norte de Europa, se emplea aceite de colza o canola para producir biodiesel, mientras que en el Sur de Europa se emplea aceite de girasol. Cabe destacar, que cualquier aceite vegetal puede ser empleado para la producción de biodiesel, así como los sebos de vacunos, porcinos, aves y pescado. Generalmente se utiliza más la colza para la elaboración de biodiesel, ya que es más económico que otros aceites.
Los beneficios del uso del biodiesel se pueden observar desde distintos puntos; por un lado, las ventajas técnicas, a diferencia del combustible mineral, el biodiesel casi no contiene azufre y sus propiedades lubricantes permiten que los motores permanezcan en buen estado. Es un excelente sustituto del aditivo de gasolina, en su versión nafta, el biodiesel puede ser utilizado para la limpieza de los motores de vehículos de gasolina y no solo como carburante para su arranque.
• Reduce las emisiones de contaminación en los vehículos. Es uno de los beneficios más importantes, ya que disminuyen significativamente los niveles de monóxido de carbono,
hidrocarburos, azufre y otros elementos contaminantes.
• Mayor aprovechamiento del suelo. Debido a que el biodiesel es producto de aceites naturales, evita fenómenos de erosión y desertificación de los suelos. Asimismo, el hecho de que este combustible sea producto de semillas oleaginosas, ayuda al mejor aprovechamiento de las materias primas.
significativa la contaminación del agua. En el mismo sentido, el impacto ecológico del biodiesel se ve reflejado en la reducción de las emisiones de dióxido de carbono y hollín, asimismo, evita el daño a animales y plantas y cuando tiene contacto con el agua y los suelos, son procesados por microorganismo, lo que ayuda a que tiempo de su completa descomposición biológica sea muy próximo a un mes.
En cuanto al aspecto económico, la elaboración de biodiesel natural tiene un enorme beneficio para la agricultura debido a la mayor demanda y mejor aprovechamiento de las materias primas.
Símbolo con el que se representa el Día internacional del biodiesel: El uso de aceites vegetales para el combustible de los motores puede parecer insignificante hoy, pero tales aceites pueden convertirse, con el paso del tiempo, importantes en cuanto a sustitutos del petróleo y el carbón de nuestros días”. (Rudolph Diesel, 1912)

La creación y el uso del biodiesel se originaron debido a la inquietud de tener alternativas más económicas y eficientes que la máquina de vapor, a finales de 1800. El ingeniero Rudolf Diesel fue el encargado de poner en marcha los motores de biodiesel, lo novedoso de este nuevo combustible fue que funcionaba con aceites naturales de semillas oleaginosas. Actualmente este combustible suele elaborarse a base de aceites vegetales reciclados, lo que reduce de manera
Fuentes:
• Agencia Informativa Estatal de Azerbaiyán (2020). ¡0 de agosto Día Internacional del biodiesel. https:// azertag.az/es/xeber/10_de_ agosto_Da_Internacional_de_la_ Biodiesel-1557021




• Emiliano Huergo (2021), Bioeconomia, En el día internacional del biodiesel repasamos por qué es un combustible estratégico para la región: https://www. bioeconomia.info/2021/08/10/diainternacional-del-biodiesel/
• Biodiesel Argentina. (2020). 10 de agosto: día internacional del biodiesel. https://biodiesel.com.ar/14605/10de-agosto-dia-internacional-delbiodiesel



• Ziolorios. (2020). ¿Qué es el biodiesel? Conoce las ventajas y desventajas de este combustible. https://www. zoilorios.com/noticias/que-es-elbiodiesel-ventajas-y-desventajas
• Wikipedia (2022). Rudolf Diesel: https:// es.wikipedia.org/wiki/Rudolf_ Diesel
• Wikipedia (2022) Diesel: https:// es.wikipedia.org/wiki/ Di%C3%A9sel
El Ministerio de Energía del Gobierno de Indonesia realiza pruebas en carretera para dos tipos de biodiesel B40 que contiene un 40% de aceite de palma, a fin de determinar para fin de este año 2022 si estos combustibles son adecuados para uso en otros tipos de automotores, según informó la agencia Reuters.
En la actualidad, el gobierno exige que todo el diesel vendido en el país contenga un 30% de aceite de palma (B30), la mezcla obligatoria más alta en todo el mundo.
Indonesia, el principal productor mundial de aceite de palma, tiene planes a largo plazo para aumentar la concentración de aceite vegetal en los combustibles para transporte en un intento por reducir la emisión de contaminantes y de importación de combustibles.
El año pasado, el país realizó su primer vuelo de prueba utilizando combustible para aviones mezclado con aceite de palma.
Los combustibles que se probarán en los próximos meses son el diésel mezclado con un 40% de ésteres metílicos de ácidos grasos (FAME), conocido como B40 y el B3D10, que es un diésel con un 30% de FAME mezclado con un 10% de diésel verde, refinado, blanqueado, además de aceite de palma desodorizado (RBD).
Las mezclas se probarán en 12 de los modelos de automóviles de pasajeros y vehículos comerciales más populares a lo lago de 50,000 km y 40,000 km, respectivamente, según señala el titular de energía renovable del Ministerio de Energía de Indonesia, Dadan Kusdiana. “Hemos mejorado las especificaciones de combustible para que sean mejores que el B30”, señaló el funcionario.
Camiones con nuevo biodiesel transitan por algunas carreteras de Indonesia

Los esfuerzos para aumentar las concentraciones de FAME en el biodiesel enfrentaron la resistencia de los usuarios que se quejaron de que -según el informe- requería un manejo y equipo especiales debido al efecto solvente del combustible que podría corroer los sellos del motor y de los materiales de las juntas.
Se realizarán verificaciones completas en cada vehículo durante y después de realizar las pruebas para revisar el impacto de los combustibles en la maquinaria de los automotores, dijeron las autoridades.
El gobierno había dicho anteriormente que el biodiesel B35 estaría disponible a partir de julio de este año, pero esta medida se pospuso, según el informe. Se realizaría una prueba de laboratorio B35 por separado, señaló Kusdiana.
Se pronostica que el consumo de biodiesel de Indonesia será de, al menos, 10.150 millones de litros al año y el gobierno espera que B40 aumente el consumo total de biodiesel hasta en 3.500 millones de litros/año. La capacidad de producción actual del país es de 18.000 millones de litros/año.
La revista Nature (Julio 2022) anuncia que, con pesar, se ha recibido la mala noticia de que la bella y polinizadora Mariposa Monarca está ahora en la “lista roja”; es decir que es una de las especies de insectos en peligro de extinción. (Foto: ShutterStock)
La destrucción de su hábitat, la agricultura intensiva, uso excesivo de agroquímicos, el cambio climático y la disminución de su alimento, son causa de la disminución de la Mariposa Monarca ( Asclepias spp ), condiciones que las larvas de este insecto polinizador necesitan para sobrevivir.
La Mariposa Monarca, especie migrante, que cada año realiza un viaje épico desde el centro de México hasta las tierras del sur de Canadá, se encuentra ahora en

la “lista roja”. La Unión Internacional para la Conservación de la Naturaleza (IUCN - International Union for the Conservation of Nature) ha añadido la especie de mariposa Danaus plexippus plexippus a esta lista roja por vez primera: se estima que la población en Norte-América ha disminuido en cerca de un 72% durante los últimos diez años. “De la plantación nativa de ‘hierbasde-leche’ y el uso de pesticidas para eliminar esta hierba que se desarrolla en sitios en donde habita la mariposa y
le sirve para alimentar a las larvas, por acción de ciertos pesticidas, la mariposa ha desaparecido casi por completo, y por tanto, la disminución de estos pesticidas y –quizá- la reforestación de esta hierba en sitios específicos ayude a la recuperación de este importante insecto, afirma Anna Walker, bióloga conservacionista, que espera que la mariposa monarca se recupere. (Nature / Associated Press / IUCN/ July 2022).
El Archivo de Indias en Sevilla guarda la relación del avituallamiento y alimentos que cargaron en las naves: una dieta rica en calorías en donde el pan de “trigo de barco”, el aceite de oliva, las grasas animales, vino, vinagre y algunos vegetales y frutas, fueron los alimentos clave para sobrevivir largas jornadas en el mar.
La nao Victoria. Aunque muy averiada, fue la única de las cinco que salieron de Sevilla en 1521 con la expedición de Magallanes y completó el viaje con el regreso a Sanlúcar de Barrameda en 1522 bajo el comando de Juan Sebastián Elcano, ya que Fernando de Magallanes había muerto en Filipinas. (Grabado: Ortelius. Maris Pacifici Nao Victoria – Otoño de 1522).

Cinco naves o naos listas para emprender un turbulento viaje: Santiago, Trinidad, Concepción, San Antonio y Victoria , con 265 marineros de gran destreza, audacia y ambición, inician esta increíble expedición; todo, con el objetivo de ir en búsqueda de las codiciadas especias: clavo, nuez moscada, canela y pimienta , además de otras riquezas: quizá oro y piedras preciosas de La India y seda de China, tesoros que Marco Polo (Venecia 1254-1324) en la Edad Media y, gracias los cálculos de Eratóstenes (Alejandría 276 a.C – 194 a.C) y de Paolo dal Pozzo Toscanelli (Florencia 1397-Florencia 1482), tenían la certeza y mapas de que la Tierra es redonda y habían calculado (erróneamente) su circunferencia; así que, mucho tiempo después Cristóbal Colón (Génova 1451Valladolid 1506) durante el Renacimiento, emprendió el viaje marítimo a las Indias Orientales – Las Molucas (Indonesia), lugar al que no llegó, porque primero llegó a tierras americanas; aunque, hay que reconocer que Colón encontró la ruta de ida y vuelta España-Tierras americanas-España.
En esos años estas grandes exploraciones eran todavía inciertas porque aunque ya tenían la tecnología (astrolabio, sextante y otros instrumentos), algunos mapas, destreza para orientarse con el sol y las estrellas, y alimentos apropiados, más no suficientes para largas travesías como pueden ser los cítricos; además, aunque ya contaban con el avituallamiento necesario para realizar largas jornadas, todavía había muchos riesgos. De cualquier forma ya sabían que era posible dar la vuelta a la Tierra por el océano y llegar a las Indias Orientales y Las Molucas (Indonesia), así que, al mando de Fernando de Magallanes (Portugal 1480-Filipinas 1521) el grupo de marineros que salieron de Sevilla a recorrer mares desconocidos se enfrentan a mares en total calma, en contraste con mares con vientos favorables, o con peligrosas tormentas, marejadas, torbellinos y otros peligros, como fueron las corrientes y turbulencias que se presentan al encuentro de los océanos Atlántico y Pacífico,
pero que gracias a la habilidad de Magallanes lograron cruzar y llegar a su destino. Ruta que se conoce como “Estrecho de Magallanes” en la Patagonia-tierra de Fuego, entre Argentina, Chile y la Antártida.
Fernando de Magallanes , militar, explorador, marino y navegante, al servicio del rey español Carlos I, reunió a un grupo de marineros en 1519 que iniciaron una expedición para ir en búsqueda de las “islas de la especiería”.
Una vez que habían llegado al Pacífico, navegaron durante tres angustiosos meses hasta que por fin fondearon en la isla de Guam archipiélago de las islas Marianas y después a las Filipinas, en donde Magallanes, en una batalla con los pobladores de la región, perdió la vida a manos del jefe tribal Lapulapo. Pero el viaje continuó al mando de Juan Sebastián Elcano (España 1486-Océano Pacífico 1526 según algunas fuentes), llega a Las Molucas, carga especias y tesoros, y después de casi tres años de travesía y con los datos que registró paso a paso el veneciano Antonio Pigafetta se sabe que navegaron desde el Atlántico al Pacífico y después por el Índico, bordeando África hasta llegar a Sanlúcar de Barrameda y regresar a Sevilla en 1522 con una nave con tan solo 18 marineros. Habían recorrido 36,692 millas náuticas (unos 85,700 kilómetros), y habían perdido otras cuatro naos en diferentes circunstancias y 247 marineros habían muerto en accidentes, enfermedades, pleitos, motines y otras causas.
La nao Victoria fue la única que regresó a España, y llegó tan maltrecha y desvencijada que al llegar a Sanlúcar de Barrameda tuvo que ser arrastrada por otro barco hasta el puerto y seguir hasta Sevilla en 1522 en donde Elcano (según algunas fuentes) y sus hombres, y gran parte de las riquezas, fueron recibidos por las autoridades de la ciudad y un gran público que los aclamaron con gran júbilo y fiestas.
Y, durante tres meses Magallanes y sus marineros navegaron en el Pacífico sin tener contacto con tierra firme
Una vez aprobado el presupuesto para la expedición por el rey Carlos I de España, Magallanes invirtió meses en hacer los cálculos para saber qué es lo que debía llevar a bordo y cuáles eran los alimentos indispensables para un total de 265 marineros (otras fuentes señalan 240 marineros).
En el Archivo de Indias de Sevilla se guarda un legajo en donde está anotada la relación de alimentos, aparejos y pertrechos de la expedición, un asombroso inventario que desvela la capacidad del marino para calcular un viaje tan complejo y lleno de incertidumbres.
Magallanes sabía que el objeto más insignificante, una vez iniciado el viaje ya no puede recuperarse, así que cada rollo de estopa, cada pedazo de plomo, cada gota de aceite, cada metro de tela para el velamen, cada herramienta, cada cuchillo y cada hacha, y muchos otros objetos representan algo que ni con todo el oro del mundo podrían adquirirse.
para recuperar agua de lluvia. También llevaban algunos cerdos y gallinas vivas.
Alguna vez pescaban peces, tortugas, algún cetáceo o calamares.
Todos los barcos llevaban a bordo un encargado de repartir el alimento diario y varios encargados, “…el despensero, cuyo trabajo consistía en repartir primero los bastimentos que están cercanos a corromperse para que se gasten antes, proveer a todos de manera que nadie se quede sin ración y pesar y medir muy bien los alimentos” (Carla Rahn Phillips, de la Universidad de Minnesota. Revista Andalucía en la Historia, 2015).
Fernando de Magallanes, Juan Sebastián Elcano y 265 marineros en cinco naos se adentraron en busca de una ruta occidental por el Atlántico, bordeando Brasil y Argentina hasta cruzar el peligroso estrecho que conecta con el Pacífico y les lleva a las Indias Orientales y Las Molucas, en donde cargaron las especias y otros tesoros, iniciando el regreso bordeando las costas de África hasta terminar este primer larguísimo viaje. Completaron, por tanto, el sueño de Cristóbal Colón y crearon su propio sueño de abrir nuevas rutas comerciales, culturales y científicas.
Entre las cantidades que se cargaron en las bodegas, estaban veintiún mil trescientas ochenta libras de galleta de barco, cinco mil setecientas libras de carne de tocino, doscientos barriles de sardinas, novecientos ochenta y cuatro ristras de queso en aceite y para aceitunas, cuatrocientas ristras de ajos y cebollas, mil quinientas doce libras de miel en ánforas, tres mil doscientas libras de uva de Málaga, tres toneles de jerez en tinajas; botijas vidriadas con capacidad para almacenar hasta 12,000 litros de aceite de oliva para alimentos y base para preparar ungüentos y bálsamos, y lámparas de aceite de oliva y quizá de ballena; cientos de barriles de agua dulce, además de recipientes
Gran acontecimiento de nuestra historia, de la historia mundial, que debemos valorar como se merece.
· Archivo General de Indias en Sevilla, España. Con registros anotados por el veneciano Antonio Pigafetta y otros datos que se encuentran en este Archivo.
· Instituto Histórico y Geográfico (IHGB) de Río de Janeiro, Brasil con motivo del Cuarto centenario del viaje de Fernando de Magallanes alrededor del mundo. (2019).
¿Cómo calcular el avituallamiento para un viaje que no se sabe cuánto durará? ¿Qué debía comer la tripulación?
Cítricos contra el temido escorbuto fueron cargados en la nave de los alimentos: en especial membrillo, uvas, frutas y verduras, pero no fueron suficientes
L a palabra ‘agricultura’ proviene del latín ager, agri (campo) y cultura (cultivo), y se define como el “arte de cultivar la tierra”; se refiere a la actividad milenaria (ente 9 y 10 mil años) que se ocupa del cultivo del suelo, desarrollo y recolección de las cosechas, la explotación de bosques y selvas, la cría y el desarrollo de ganado, aves y otras especies, con el fin primordial de producir alimentos para los seres humanos, los animales y para otros usos no-comestibles e industriales.
La agricultura moderna emplea todos los recursos que proporciona la ciencia y la técnica: selección de semillas, utilización de fertilizantes y abonos orgánicos y químicos, así como diferentes sistemas de riego y protección de los vegetales contra parásitos y plagas. Los procesos y sistemas agrícolas cada vez son más mecánicos, lo que determina un incremento constante del rendimiento de las tierras, indispensable para contar con alimentos para una población en constante aumento -más de 7,000 millones- en todo el mundo.
Hay evidencias arqueológicas de que la siembra de la tierra -la agriculturafue descubierta por las mujeres, y se desarrolló con el objetivo de
En todo el mundo, por su importancia para la sobrevivencia de la humanidad la FAO invita a todas las personas a conmemorar el Día Mundial de la agricultura, con el objetivo de crear conciencia y valorar sus impactos en los suelos, el agua, la biodiversidad y en diferentes aspectos de la vida cultural (Foto: ShutterStock)

cubrir las necesidades básicas de alimentación de las personas. Cultivar la tierra, con el fin de llegar a producir alimentos de autoconsumo y, más tarde, comercializar los excedentes, lo cual permitió que la humanidad introdujera cambios sumamente importantes, como el sedentarismo, la urbanización, la formación de instituciones, el invento de la numeración, la escritura y los cálculos matemáticos y astronómicos,
lo cual transformó por completo el transcurso de la historia.
En los primeros asentamientos humanos estables, de pueblos que dejaron de ser nómadas, comenzaron a domesticar algunos animales, sembrar granos y semillas y, cosechar sus productos sin necesidad de salir a buscarlas, lo que junto a la utilización de herramientas -como el azadón y el arado- provocó una
revolución completa que marcó el fin de una época basada en la recolección y la caza, y el comienzo de la primera revolución agrícola y ganadera como modo de vida.
Hoy en día, millones de personas dependen de la agricultura para su subsistencia, misma que suele ser el motor de la economía de los países desarrollados. La agricultura constituye una de las actividades más importantes para poner fin a la pobreza extrema. Sin embargo, el crecimiento económico generado por la agricultura y producción de alimentos, logró reducir la pobreza y aumentó la seguridad alimentaria, adelantos que hoy en día se encuentran en riesgo, debido a que si se emplea esta actividad de manera extensiva o sin la tecnología adecuada, obliga a los productores a abrir nuevas tierras agrícolas y causa deforestación de ecosistemas, sobre-explotación de recursos hídricos de gran valor y al uso de grandes químicos que pueden dañar los suelos y el agua; entre ellos, fertilizantes, plaguicidas y herbicidas.
Los cultivos desarraigados de la naturaleza generan desequilibrios en el suelo, empobreciéndolos y haciéndolos altamente vulnerables a enfermedades y plagas, además contaminan los acuíferos y cursos de ríos y lagos. Por otro lado, los actuales sistemas alimentarios también amenazan la salud de las personas y del planeta y generan niveles insostenibles de contaminación y desechos. Un tercio de los alimentos producidos en el mundo se pierde o se desperdicia, y es imperioso abordar este problema para mejorar la seguridad alimentaria y nutricional, así como para contribuir a alcanzar los objetivos relacionados con el clima y a reducir las presiones sobre el medio ambiente.
Debido a esta situación, el 9 de septiembre se conmemora el día internacional de la agricultura, con el objetivo de concientizar a la población acerca del gran trabajo que realizan los agricultores, el impacto de esta actividad en el desarrollo económico y social de la población mundial, el impacto de la agricultura a gran escala en el medio ambiente y las dificultades que enfrentan los agricultores debido a los efectos del cambio climático.

La aceleración del cambio climático podría disminuir aún más el rendimiento de los cultivos, especialmente en las regiones con mayor inseguridad alimentaria. Además, las actividades agrícolas y forestales y los cambios en el uso de la tierra son responsables de alrededor del 25 % de las emisiones de gases de efecto invernadero. Las medidas de mitigación en el sector de la agricultura son parte de la solución para el cambio climático.
Los actuales sistemas alimentarios también amenazan la salud de las personas y del planeta y generan niveles insostenibles de contaminación y desechos. Cabe destacar que, un tercio de los alimentos producidos en el mundo se pierde o se desperdicia, por eso es importante abordar este problema para mejorar la seguridad alimentaria y nutricional, así como para contribuir a alcanzar los objetivos relacionados con el clima y a reducir el impacto sobre el medio ambiente.
Los riesgos asociados con las dietas deficitarias también son la principal causa de muerte en todo el mundo . Millones de personas no comen lo suficiente o consumen alimentos inadecuados, una doble carga de malnutrición que puede conducir a enfermedades y crisis sanitarias.
La organización de las Naciones Unidas para la Alimentación y la Agricultura (FAO) propone cinco principios para alcanzar una agricultura sostenible a nivel mundial:
La agricultura, no es tan solo un trabajo, e una forma de vida que tiene un gran impacto socio-cultural en diversas poblaciones alrededor del mundo
• Mejorar la eficiencia en el uso de los recursos es fundamental para la agricultura sostenible
• La sostenibilidad requiere acciones directas para conservar, proteger y mejorar los recursos naturales
• La agricultura que no logra proteger y mejorar los medios de vida rurales y el bienestar social es insostenible
• La agricultura sostenible debe aumentar la resiliencia de las personas, de las comunidades y de los ecosistemas, sobre todo al cambio climático y a la volatilidad del mercado
• La buena gobernanza es esencial para la sostenibilidad tanto de los sistemas naturales como de los sistemas humanos
Actualmente, según los datos de la Organización de las Naciones Unidas para la Alimentación y la Agricultura (FAO), los pueblos indígenas, después
de cientos de años de selección de cultivos y pruebas, suelen cultivar una variedad de especies nativas y una multitud de variedades que se adaptan mejor a los contextos locales y son a menudo más resistentes a la sequía, la altitud, las inundaciones u otras condiciones extremas, porque más allá de las estadísticas comerciales, para comunidades indígenas, la agricultura es vista como forma de vida, patrimonio, identidad cultural y contacto directo con la naturaleza. Es importante hacer conciencia y comenzar a realizar cambios en el estilo de la población, ya que una agricultura desmedida, no solo afecta ambientalmente, también tiene impactos en el desarrollo social y alimentario a nivel mundial.
• Agencia EFE. 2020. Día mundial de la agricultura: Momento perfecto para reconocer el trabajo en
el campo: https://www.efe.com/efe/america/ comunicados/dia-mundial-de-la-agriculturamomento-perfecto-para-reconocer-el-trabajodel-campo/20004010-4338202
• FAO. La importancia de la agricultura en la actualidad. https://www.fao.org/3/a0015s/ a0015s04.htm
• Banco Mundial. 2022. Agricultura y alimentos. Panorama General: https://www. bancomundial.org/es/topic/agriculture/ overview#:~:text=La%20agricultura%20 puede%20ayudar%20a,dedican%20 principalmente%20a%20labores%20 agr%C3%ADcolas.
• Greenpeace. 2021. Día internacional de la agricultura: restaurar los ecosistemas. https:// www.greenpeace.org/mexico/blog/49053/ dia-internacional-de-la-agricultura-restaurarlos-ecosistemas/#:~:text=Este%209%20de%20 septiembre%20se,alimentos%20para%20el%20 consumo%20humano.
• Organización de las Naciones Unidas para la Alimentación y la Agricultura. 2022. Objetivos de desarrollo sostenible: https://www.fao.org/ sustainable-development-goals/overview/faoand-post-2015/sustainable-agriculture/es/








más de
DE METAL
DE GRASA
PRENSA, DE PRESION Y PULIDO LIMPIADORAS
de las Industrias de Proceso
USADOS
Frasco de aceite de Argán. Se obtiene del fruto del árbol Argán, en cuyo interior se encuentra una nuez que, a su vez, tiene que ser abierta para obtener las semillas oleaginosas.

El Argán (Argania spinosa) es un fruto proveniente de los arboles endémicos de los suelos semi-desérticos de Marruecos, territorio que abarca un gran territorio, hasta la Hamada de Tinduf en Argelia. Además, poco a poco este árbol ha sido cultivado en distintos desiertos de Sudáfrica, España, Kuwait, México (cultivo todavía en prueba) y Túnez, Israel, entre otros países del mundo.
El árbol de argán puede sobrevivir a temperaturas de más de 50°C ya que se adapta a la sequia y a un suelo pobre, sus raíces tienen la capacidad de extenderse buscando agua, lo que ayuda a fijar el suelo y evitar la erosión, razón que ha permitido a la región resistir el avance del desierto del Sahara; por esta cualidad es sumamente importante para el equilibrio del medio ambiente en Marruecos.
La mayoría de los estudios, señalan que el argán es un árbol endémico de Marruecos y su aceite fue procesado por los bereberes de esta región (1,200 a.C). Existen evidencias que afirman que los Fenicios comercializaban este aceite por el Mediterráneo, desde el Magreb hasta el Nilo. Fue un aceite bien conocido por los griegos, romanos y árabes, muy apreciado por sus cualidades terapéuticas y cosméticas.
A finales del siglo XX el árbol Argán estuvo a punto de desaparecer debido a un cambio en las políticas de cultivo; sin embargo y debido a las cualidades y beneficios culinarios, terapéuticos y cosméticos, la UNESCO declaró en 1998 la Reserva de la Biósfera (Arganiae) de 2.5 millones de hectáreas al suroeste de Marruecos, y el 10 de mayo ha sido declarado por las Naciones Unidas como el Día Mundial de los Arganes.
El aceite de argán es derivado del fruto del árbol, la nuez que contiene un máximo de tres semillas sumamente delicadas que, requieren mucho cuidado para su extracción, ya que las que terminan rotas o golpeadas suelen oxidarse rápidamente y es difícil que proporcionen un aceite de buena calidad. Cabe destacar que no todas las semillas son iguales, hay varios criterios para diferenciarlas como el color, el lugar de origen o por los daños que sufren durante la extracción, estos factores siempre influyen directamente en la calidad de la materia prima y en consecuencia, en la calidad del aceite.
Este aceite es conocido como “oro rojo”, es uno de los más preciados en el mundo y el aceite comestible más caro del mundo. Es rico en vitamina A (acido retinoico), vitamina E (que ayuda al proceso de renovación celular en la piel) y en ácidos grasos esenciales. Debido a sus múltiples beneficios, el aceite de argán es comercializado de manera comestible y, sobre todo, para uso cosmético.
El aceite de argán comestible se obtiene de las semillas de argán que previamente han sido ligeramente tostadas. El aceite de argán comestible tiene un color moreno, muy parecido al de la miel, no es turbio y tiene un aspecto brillante; ya que es un producto bastante sensible a la luz, debe mantenerse preferentemente en un lugar obscuro. Gracias a su alto contenido de ácidos grasos esenciales, el aceite de argán ayuda al tratamiento de hipercolesterolemia, al reducir la absorción del colesterol en el intestino; enfermedades cardiovasculares y reumáticas; contiene propiedades antitumorales debido a su contenido de espinasterol; es una gran fuente de antioxidantes, ya que es rico en tocoferoles y mejora el funcionamiento hepático.

En cuanto a sus beneficios terapéuticos, el aceite de argán puede ayudar en los tratamientos de la piel, combatiendo enfermedades como el acné, psoriasis (afección en la que las células de la piel se acumulan para formar escamas y manchas secas que producen comezón.) y el eccema (término que designa diferentes tipos de hinchazón de la piel. También se llama dermatitis), así como el apoyo en la cicatrización y en la disminución de estrías. Beneficia la hidratación corporal y del cabello, y retrasa el envejecimiento cutáneo. Como cosmético, el aceite es un magnífico emoliente, por lo que se utiliza en el cuidado de la piel y el cabello.
Botella decorativa tradicional de Marruecos con aceite y frutos de argán.
El aceite de argán es elaborado por cooperativas de mujeres bereberes de Marruecos y esto colaboró a que esta industria se convirtiera en un negocio millonario mediante la participación de las mujeres. En 2010, las mujeres tenían una ganancia aproximada a los 6 euros diarios, esto es diez veces superior a lo que ganaban anteriormente con la producción de aceite de argán por su cuenta. Desde hace siglos se ha utilizado el mismo método para fabricar este aceite. El primer paso es la recolección de los frutos maduros y caídos del árbol de argán; posteriormente, los frutos recolectados se dejan secar en el sol antes de pelarlos a mano para que se pueda extraer la capa externa carnosa; el fruto seco del árbol de argán es el que se rompe para poder extraer la semilla que contiene el aceite de argán. Para extraer un litro de aceite de argán se necesitan aproximadamente 40 kg de fruto o 20 kg de nueces. La siguiente etapa es la molienda, que regularmente se realiza a mano con una trituradora de piedra, es el método tradicional marroquí, en el cual se le invierten aproximadamente 2 horas para un litro de aceite; asimismo, cuentan con una maquina más grande y sofisticada tecnológicamente para cuando tienen que producir cantidades mayores de aceite en menor tiempo; en cinco minutos puede producir entre uno y dos litros de aceite. En el proceso artesanal de un litro de aceite de argán se invierten aproximadamente 24 horas por mujer, por esta razón el aceite de argán tiene un valor muy elevado.
La pulpa extraída del fruto de argán se vende como alimento para los animales, particularmente las cabras gustan de este fruto, por esta razón es muy común ver cabras sobre las ramas de los arboles en Marruecos.

La importancia del árbol de argán radica en el impacto socioeconómico, ya que por un lado, el fruto del argán y su aceite funcionan como alimento para la sociedad marroquí; y por el otro, su venta y la creación de las cooperativas han apoyado al comercio y la internacionalización del producto; por lo tanto la economía de las mujeres ha mejorado bastante. Por las razones anteriormente mencionadas el gobierno marroquí ha impulsado de protección del árbol como indicación geográfica (UNESCO, 1998).
Naciones Unidas. 2022. Día Internacional de los Arganes 10 de mayo: https://www.un.org/es/observances/arganiaday#:~:text=Y%20por%20%C3%BAltimo%2C%20 en%202021,como%20D%C3%ADa%20Internacional%20 del%20Arg%C3%A1n.
Organización Mundial de la Propiedad Intelectual. Una indicación geográfica que ayuda proteger la sociedad y el medio ambiente: https://www.wipo.int/ipadvantage/es/details. jsp?id=2656
Eccoverde. Beneficios del Aceite de Argán para tu piel y cabello: https://www.ecco-verde.es/info/beauty-blog/beneficios-delaceite-de-argan-para-tu-piel-y-el-cabello.
El aceite de argán (Argania spinosa L., Familia Sapotaceae) presenta las siguientes características físico-químicas: Es un liquido transparente de color ámbar, prácticamente inodoro, de textura muy fina y tacto no-graso. Posee una composición similar al aceite de sésamo (ajonjolí o alegría), con un 80% de ácidos grasos insaturados, principalmente ácido oleico (45%) y linoleico (35%) así como ácidos grasos esenciales (palmítico y esteárico), y fitoesteroles (Offarm-Elsevier). El aceite de argán virgen, se compone de 99% de acil-glicéridos (principalmente triglicéridos).
La materia insaponificable que representa el 1% restante, está compuesta de carotenos, tocoferoles, alcoholes triterpénicos, esteroles y xantofilas (Arganium Life.com), y es muy rica en antioxidantes. El contenido de vitamina A y E es superior al del aceite de oliva. También contiene compuestos fenólicos -los ácidos ferúlico y siríngico- así como esteroles -eschofenol y espinasterol- que no están presentes en el aceite de oliva ni en otros aceites vegetales. Es muy estable, por lo que permite su conservación durante al menos dos años sin que pierda sus cualidades. (Offarm-Elsevier).
La disminución de antibióticos en los animales es la primera estrategia que hay que seguir para garantizar la seguridad de toda la cadena agroalimentaria. La resistencia a los antibióticos se ha incrementado en todo el mundo, lo cual se convierte en una amenaza a la salud porque se pierde la eficacia a cualquier tratamiento antimicrobiano. Para combatir la resistencia antimicrobiana (AMR por sus siglas en inglés), la FAO recomienda que todas las naciones adopten programas que tiendan a prevenir este grave problema.
En principio, es necesario que se atienda al AMR. Investigadores del Center for Strategic and International Studies (CSIS), Global Food Security Program, señalan que “el AMR es una amenaza real para la seguridad alimentaria global porque desestabiliza los alimenticios y la salud de las comunidades”.
Caitlin Welsh, Director de CSIS del Programa de Seguridad Global para la Seguridad Alimenticia, resaltó el riesgo que afecta a toda la cadena alimenticia por aumento de la resistencia antimicrobiana lo que impone la puesta en marcha de medidas de prevención urgentes, ya que este problema fue la causa de que fallecieran 1.3 millones de personas en todo el mundo en 2019; sobre todo en personas que están afectadas por algún padecimiento crónico.
antimicrobiana (AMR) es la habilidad de los microorganismos para permanecer o aumentar su presencia en los medicamentes asignados para inhibir o eliminar estos patógenos. Estos medicamentes se crean resistencia contra las bacterias, hongos, virus, y parásitos de protozoarios. Cuando los microorganismos se hacen resistentes a los antimicrobianos, los tratamientos habituales a menudo ya son totalmente ineficaces, y en algunos casos, ningún medicamente puede proporcionar una terapia efectiva. Por consecuencia, cualquier tratamiento fracasa. Esto incrementa el padecimiento y la mortandad en los seres humanos, los animales y las plantas.
En Dinamarca se lleva a cabo un programa de salud animal, porque la salud de los animales constituye el primer eslabón y fundamento para disminuir el consumo de antibióticos, y prevenir el AMR, señaló Rasmus Prehn, Ministro de Alimentos, Agricultura y Pescadería de Dinamarca, y resaltó la importancia de prevenir, para optimizar la salud de las personas, animales y ecosistemas. Dinamarca es uno de los países que utiliza un mínimo de antibióticos, sobre todo en animales, como el ganado, las aves y los cerdos. Como certificado, los productores tienen que conseguir una tarjeta amarilla que
La FAO recomienda a todas las naciones disminuir la administración de antimicrobianos y aplicar en forma constante vacunas, empezando por los animales para el consumo humano, que son el inicio de toda la cadena agroalimentaria.
sea una garantía de que los animales no han sido tratados con antibióticos. Esta es una de las estrategias más importantes para reducir la incidencia de AMR.
Junxia Song, Oficial de Salud Animal de la FAO y encargada de prevenir AMR a nivel internacional, señaló que el problema de la resistencia antimicrobiana es complejo y afecta los sistemas agroalimentarios. Uno de los problemas, explicó Song es el aumento de los costos en el tratamiento de padecimientos lo que obliga a buscar nuevas fórmulas más eficaces. Song señaló que una de estas estrategias para disminuir el uso de antimicrobianos es la vacunación, porque con ello se disminuyen las enormes pérdidas en todos los sistemas agroalimentarios que son un problema para los productores de carne por lo difícil de destruir patógenos que cada vez se vuelven más resistentes a cualquier tratamiento. Por esta razón se recomienda la vacunación y reducir al máximo el uso de antimicrobianos. (https://www,fao,org/antimicrobial resistance/ en/ Organización de las Naciones Unidas para la Alimentación y la Agricultura. Junio 2022).
Este libro editado por Frank J. Flider en colaboración de muchos investigadores y expertos en diversas disciplinas constituye la primera referencia completa para conocer las ca racterísticas y aplicaciones de esta nueva y dinámica categoría de grasas y aceites que son esenciales para reemplazar el proceso de hidrogenación parcial de los aceites líquidos, por muchos años necesarios para la elaboración de mantecas y margarinas necesarias para frituras y panadería.
Con fundamento en una enorme experiencia comercial y cien tífica, seminarios y presentaciones, el editor Frank J. Flider ha identificado preguntas y dudas de diversos usuarios, necesidades y temas concernientes a los aceites alto-oleico, con descripción y explicación de las características de este tipo de aceites, desa rrollo, composición y utilización, de gran valor para los lectores, incluyendo investigadores y procesadores en la industria aceitera y de alimentos procesados, en especial de materias primas como mantecas, margarinas, grasas y otros.
• Detalles del desarrollo de la tecnología que ha hecho posible la fabricación de aceites alto-oleico a gran escala.
• Describe las cualidades nutricionales y ventajas de la com posición de este tipo de aceites en comparación con otros.
• Presenta datos objetivos derivados de la investigación cientí fica sobre la comprensión de los aceites monoinsaturados-n9 con altos niveles de ácidos grasos alto-oleico.
• Analiza las diversas técnicas y procesos para obtener semillas mejoradas con alto contenido de ácidos grasos alto-oleico.
El objetivo de este libro es proporcionar recursos necesarios para la comprensión en el desarrollo, propiedades y usos de los diversos tipos de aceite alto-oleico. El primer capítulo ofrece una visión del proceso de hidrogenación parcial de los aceites líquidos y cómo paulatinamente este proceso se ha logrado eliminar. Dos capítulos están dedicados al análisis de lo que sucede con los aceites que en forma natural contienen importantes cantidades de ácido graso alto-oleico; en especial el de oliva y el de aguacate. Los capítulos siguientes analizan las características de aceites individuales alto-oleico como el de oliva, aguacate, girasol, soya, y canola con descripción detallada del proceso que han seguido los investigadores para obtener este tipo de aceite, incluyendo el uso de biotecnología y técnicas para la producción de semillas mejoradas. Se describen las propiedades de esta clase de aceites en di ferentes usos, de gran utilidad en la industria farmacéutica, química, de cosméticos, y otras de uso no-comestible.

Frank J. Flider (Editor)
AOCS Press and Academic Press Elsevier
Primera edición: 25 noviembre 2021
Páginas: 548
Idioma: Inglés
El aceite alto-oleico procedente de diversas semillas y granos se está utilizando cada vez más en frituras, y otros usos para me jorar la estabilidad e incrementar la vida de anaquel de muchos productos alimenticios. Otro capítulo está dedicado al desarrollo futuro del aceite alto-oleico y algunas de las varias técnicas y mé todos que pueden utilizarse en su desarrollo. Además de su gran estabilidad oxidativa, los ácidos grasos monoinsaturados se con sidera que son benéficos para una buena nutrición y para la salud cardiovascular. En otro capítulo se describe su valor nutricional.
Finalmente, en cuanto que este tipo de aceite va en aumento, es importante entender el suministro de esta materia prima, demanda y aspectos económicos, por lo que uno de los capí tulos del libro está dedicado al análisis de este tema.
El nivel de experiencia y conocimientos de los autores que han contribuido en la elaboración de este libro es realmente sorprendente, por lo cual, tanto el lector como muchos lec tores agradecen las colaboraciones que sin duda alguna serán de gran beneficio para todos aquellos que están interesados en el desarrollo y aplicación del aceite alto-oleico que es una importante referencia al estudio de los aceites y las grasas vegetales comestibles que en los últimos años han alcanzado niveles importantes.
“E n muchos sentidos mi padre, fue un cazador-recolector” recuerda James Eprhaim Lovelock (Inglaterra 1919 - ) sentado en una banca del patio de su casa de campo sobre Chesil Beach, en la costa sur de Inglaterra. Lovelock vivió su niñez y juventud en un hogar de escasos recursos, su padre luchaba por alimentar a la familia, pero a la vez inculcó en el joven Jim la virtud de observar y respetar la naturaleza y la Tierra. Años más tarde, como científico, el Sr. Lovelock desarrolló la teoría de Gaia , la idea de que la Tierra es un sistema único, complejo y autorregulado. Aunque inicialmente esta teoría fue rechazada por los científicos de vida, paulatinamente se ha convertido en la forma en que muchas personas conciben el planeta.
Esa es solo una de sus muchas contribuciones a la ciencia de James Lovelock: científico, ambientalista y futurista. Lovelock perfeccionó un método para buscar vida en otros planetas mientras estaba en la NASA en la década de 1960. Encontró y cuantificó los CFC (cloro-fluoro-carbonos, responsables de la destrucción de la capa de ozono en la estratósfera) en la década de 1970, lo que finalmente condujo a la prohibición de muchas de las sustancias químicas que son dañinas para los ecosistemas, la salud del ser humano y de todos los seres vivos. Su nominación a la Royal Society de Gran Bretaña en 1974 citó una plétora de trabajos en biología, química
y física, todo antes de la popularización de la teoría por la que es más conocido (que lleva el nombre de Gaia, la antigua diosa griega de la Tierra).
Para coincidir con su cumpleaños número 100, Lovelock ha publicado un pequeño libro sobre inteligencia artificial, escrito en colaboración con el periodista Bryan Appleyard. Es algo que expande la mente. Lovelock cree que el mundo está dejando el Antropoceno (es decir, la edad geológica actual, cuando la actividad humana tiene un impacto dominante en el planeta), para entrar en la era del Novaceno, en el que los “cyborgs” (sistemas de Inteligencia Artificial -IA-) desempeñarán un papel central.
Este es el próximo paso en la selección natural, argumenta, porque los cyborgs pueden reproducirse y evolucionar. Pueden pensar miles de veces más rápido que los humanos: son tan inteligentes como las personas son más inteligentes que las plantas. No se asuste, aconseja el Sr. Lovelock, por aterrador que suene. Los cyborgs tendrán un incentivo para conservar a los humanos en lugar de eliminarlos, ya que necesitarán formas de vida que ayuden a enfriar el planeta
 James E. Lovelock
James E. Lovelock
MIT Press (Massachusetts Institute of Technology), Cambridge, MA., USA.
November, 2020.
para su propia supervivencia, aunque los mortales pueden ser relegados a la condición de mascotas y juguetes. Los cyborgs pueden “exhibir colecciones de humanos vivos”, escribe, tal como hoy en día la gente “visita Kew Gardens -en Londres- a observar las plantas”.
Al final, los sistemas de la inteligencia artificial (IA) pueden salvar tanto a la humanidad como a la misma Tierra. Además del cambio climático, Lovelock teme otras formas naturales en que Gaia, el principio que mantiene el equilibrio en el clima del planeta, podría ser destruido, como una erupción volcánica severa.
Mantener el planeta fresco lo hará más resistente a tales amenazas, sostiene Lovelock. Por tanto, además de preservar la vida orgánica, los cyborgs probablemente implementarán otros tipos de geoingeniería que reduzcan la temperatura de la Tierra. Por lo tanto, el Novaceno debe ser bienvenido, no temido: “Sea cual sea el daño que le hayamos hecho a la Tierra, nos hemos redimido justo a tiempo actuando simultáneamente como padres y parteras de los cyborgs. Únicamente ellos pueden guiar a Gaia a través de las crisis astronómicas ahora inminentes”, escribe Lovelock.
Como pensador, Lovelock, desafía la categorización. Está firmemente a favor de la energía nuclear y rechaza el movimiento verde como una utopía. Considera que el trabajo en armas autónomas es tan tonto como mortal. Atribuye su originalidad a una decisión de abandonar la academia por la investigación independiente, lo que permitió que su curiosidad se incrementara. En la era Novaceno, Lovelock sostiene un argumento que le es muy importante: señala que los humanos están imbuidos en el lenguaje que refuerza las cosas materiales y lineales a expensas de la imaginación,
la creatividad y la intuición que es una forma más verdadera de entender la realidad del mundo.
Lovelock amplía este concepto en su jardín con vista al mar. La mayoría de sus propios inventos provienen de la imaginación y de la intuición, reflexiona en un cálido día de verano, sin seguir los pasos lógicos de la ciencia. Una estatua de Gaia le devuelve la mirada desde un punto estratégico de su jardín. (Este artículo se publicó en la sección Cultura de la edición impresa de The Economist bajo el título “Elogio de los cyborgs”.
El libro que cambiará nuestra manera de pensar el problema de la pobreza y lo que debemos hacer para aliviarla.
 By Abhijit V. Banerjee y Esther Duflo – Ganadores del
Nobel de Economía 2019
By Abhijit V. Banerjee y Esther Duflo – Ganadores del
Nobel de Economía 2019
ómo se vive con menos de un dólar al día? ¿Por qué los microcréditos resultan útiles pero no son el milagro que algunos esperaban? ¿Por qué los pobres dejan pasar las campañas de vacunación gratuita pero pagan por medicinas que a menudo no necesitan? ¿Por qué sus hijos pueden ir a la escuela año tras año y no aprenden casi nada? ¿Por qué no siempre invierten en donde pueden obtener alimentos con menor cantidad de calorías, sino que eligen alimentos con enorme cantidad de calorías porque saben mejor y dejan una buena sensación de saciedad?
Nuestra tendencia a reducir a los pobres a un conjunto de clichés nos ha impedido hasta ahora, comprender los problemas a los que se enfrentan a diario. Dado que poseen tan poco, hemos asumido que no hay nada de interés en su vida económica. Las políticas gubernamentales destinadas a ayudarles muchas veces fracasan porque se fundamentan en suposiciones erradas con respecto a sus circunstancias y su conducta.
Repensar la pobreza supone un revolucionario giro en el modo de abordar la lucha global contra la pobreza. Sus autores, dos consagrados economistas del MIT, han acudido directamente a los protagonistas para comprender cómo funciona de verdad la economía de los pobres, cuáles son sus motivaciones y aspiraciones. Los resultados de sus observaciones contradicen muchas de nuestras creencias más arraigadas.
El innovador planteamiento de este libro empieza por cambiar las preguntas. A partir de ahí, ofrece las respuestas y, con ellas, un gran potencial transformador y una guía esencial para políticos, activistas y cualquier persona preocupada por construir un mundo sin desigualdad.
Esther Duflo creció en Francia sintiendo lástima por los pobres de Kolkata, según lo que había leído en un cómic sobre la Madre Teresa. Abhijit Banerjee creció en Kolkata envidiando a los niños pobres porque siempre tenían tiempo para jugar y con frecuencia le ganaban a las canicas. Tiempo más tarde, Duflo y Banerjee, como economistas se conocieron en el Instituto Tecnológico de Massachusetts, desde entonces ambos siguen con gran interés el problema de la pobreza. En este fascinante nuevo libro de estos autores, ganadores del Premio Nobel en 2919. En este nuevo libro, se basan en una intrépida investigación y una colección de anécdotas personales para
iluminar las vidas de los 865 millones de personas que, según el último recuento, viven con menos de $0.99Dlls al día (menos de $20 pesos mexicanos).
Los dos economistas se hicieron famosos (y rehicieron su disciplina) defendiendo los ensayos aleatorios. Estos ensayos prueban las posibles soluciones contra la pobreza, en una forma semejante, como las empresas farmacéuticas prueban los medicamentos. Un grupo obtiene el remedio, otro no. Los dos grupos se eligen al azar, por lo que el remedio debe ser la única diferencia sistemática entre ellos. Si al primer grupo le va mejor, el beneficio puede atribuirse al proyecto y no a los muchos otros factores que de otro modo podrían oscurecer el resultado.
Estos ensayos resultaron inmensamente atractivos. Prometieron filtrar pepitas de verdad en una mezcla de sabiduría recibida y de ilusiones que caracterizan muchas charlas de ayuda. La esperanza era que, una vez que una prueba, demostrara el valor de un proyecto o programa, los gobiernos donantes lo respaldarían y prescribirían más ampliamente.
El enfoque de Banerjee y Duflo ha recibido aprobaciones de muchos analistas, pero también ha atraído críticas. El libro, señalan los críticos, muestran si un fármaco o remedio funciona, pero no cómo funciona. Incluso en medicina, un ensayo aleatorio solo puede mostrar si el paciente promedio se beneficia; no si cualquier paciente individual se beneficiará. La fisiología humana difiere de un paciente a otro, al igual que la fisiología de la pobreza.
Poor Economics se basa en una gran cantidad de evidencias, sin limitarse a los resultados de ensayos aleatorios, como si fueran la única ruta hacia la verdad. Y el interés de los autores no se limita a “lo que funciona”, sino también a cómo y por qué funciona”. De hecho, la Sra. Duflo y el Sr. Banerjee, quizás más que algunos de sus discípulos, son teóricos capaces y empiristas minuciosos.
Están fascinados por la forma en que los pobres piensan y toman decisiones. Los pobres no son estúpidos, pero pueden estar mal informados o abrumados por las circunstancias, luchando por hacer lo que incluso ellos reconocen que es lo mejor para ellos.
Los pobres, como cualquier otra persona, también pueden sucumbir a la inercia. Los autores descubrieron que era bastante normal que las mujeres pobres de la ciudad india de Hyderabad sacaran un micropréstamo que cobraba un interés del 24% solo para depositarlo en una cuenta de ahorros que pagaba el 4%. Esto parece una locura, excepto que la obligación de pagar el préstamo aseguró que las mujeres no derrocharan el dinero. Los agricultores del oeste de Kenia pierden los beneficios de los fertilizantes porque, cuando llega la temporada de siembra, a menudo han gastado sus ganancias de la cosecha anterior. Pero los agricultores lo suficientemente previsores como para comprar el fertilizante inmediatamente después de la cosecha, cuando tienen dinero, no lo venden, a pesar de enfrentar las mismas demandas sobre sus recursos. En otras palabras, los agricultores no pueden ahorrar dinero para comprar fertilizante, pero pueden ahorrar el fertilizante físico en sí.
La pobreza a menudo se vincula en la mente del público con la dependencia. Pero, como señalan los autores, los pobres son más responsables de sus vidas que los ricos, que se pasean, disfrutan del agua clorada, cobran un salario regular, ingresan directamente a una cuenta bancaria, quizá con contribuciones a su pensión y atención médica automáticamente. Los ricos pueden satisfacer su debilidad por los cigarrillos y el alcohol sin temor a la ruina financiera. Los pobres, en cambio, tienen que vigilar cada taza de té azucarado. El Sr. Banerjee y la Sra. Duflo recomiendan una variedad de empujones, apoyos y subsidios que harán que sea tan fácil para los pobres tomar las decisiones correctas como lo es para los ricos.
Si es un error equiparar pobreza y dependencia, es igualmente erróneo creer que los pobres se levantarán por sus propios medios. El libro cruza espadas con los gurús de los negocios y los filántropos que proyectan su propio entusiasmo por el espíritu empresarial –inalcanzable quizá- en los pobres. Si, es más probable que los pobres manejen su propio negocio que el resto de nosotros. Pero es porque no tienen otra opción. Cuando se les pregunta, la mayoría aspira a un puesto en el gobierno o, a un trabajo en una fábrica. Los países en desarrollo no están llenos de miles de millones de empresarios en ciernes; esán llenos de miles de millones de asalariados en ciernes.
Banerje y Duflo abogan por lo que llaman una “revolución silenciosa”. Insisten en que las cosas se pueden mejorar “al margen”, que es la manera de un economista de decir que las cosas pueden mejorar, aunque sean muy malas. También argumentan que mejores políticas pueden contribuir a una mejor política. Una vez que los electores ven que una buena formulación de políticas puede marcar una diferencia en sus vidas, elevan sus expectativas y exigen más. (The Economist. Culture. April 2011).
· Amartya Sen. (Premio Nobel de Economía). “Un libro maravillosamente lúcido sobre la naturaleza de la pobreza”.
· Moisés Naim. El País: “El ensayo más interesante que he leído en mucho tiempo. Está lleno de sorpresas y va a cambiar nuestra manera de pensar sobre la pobreza y lo que se debe hacer para aliviarla”.
· Steven D. Levitt. Autor de Freaknomics. “Este libro debe ser de lectura obligada para cualquier persona que se preocupe por la pobreza en el mundo. Representa lo mejor que la economía puede ofrecer”.
· The Economist. “Vayamos al grano: es el mejor libro que he leído sobre el tema. No hay truco. El enfoque es directo y honesto. Y algunas de las conclusiones son sorprendentes, incluso desconcertantes”.
· David Leonhardt. The New York Times. “Un logro profundo: reúne lo major de la nueva economías y de la antigua. Se han sumergido en el mundo que los rodea, negándose a aceptar la idea de que la economía es una mera extensión de las matemáticas”.
· William Easterly. The Wall Street Journal. “Maravilloso. Han luchado por conquistar, con honestidad y rigor, un puesto de avanzada hacia la observación, el análisis y la complejidad en un mundo, el de la ayuda, que tiende a preferir los panfletos y las fotografías de famosos. Merecen ser felicitados y leídos”.
(Reseñas publicadas en The Economist. April, 2011).
En esta imagen (ShutterStock) se observan varias cabras que siguen su instinto trepador; y comprueban que en esta región semidesértica de Marruecos se mezcla de exotismo propio de las historias bereberes, y esta inusitada costumbre de las cabras en su habilidad para subirse a las ramas del argán conocido con el nombre: “oro del desierto”, para alimentarse con los deliciosos retoños y hojas. Aunque, el gusto les durará poco, porque en época de cosecha del fruto, los cultivadores bajarán a estos hábiles y comelones intrusos.

Al igual que la mayoría de los árboles, el argán -planta endémica de Marruecos-, está inmerso en historias y leyendas; desde el uso de su aceite en el antiguo Egipto hace unos 1,200 años, la historia de los Fenicios comerciando con el aceite por el Mediterráneo, hasta los testimonios que narran la época en que el argán estuvo en peligro de la extinción, y en 2014, gracias a la labor de las mujeres agrupadas en cooperativas por la defensa del argán y su aceite, lograron la declaración de la UNESCO para que la región se nombrara Patrimonio Cultural Inmaterial de la Humanidad a fin de proteger el argán, el aceite, el trabajo de las mujeres en beneficio del ser humano e incluso la extraña costumbre de las cabras trepadoras.
Lo más probable es que, como la mayoría de los árboles, el argán esté articulado alrededor del Cósmos; es decir, con la vida en continua transformación, una idea que, entre otras ideas, se demuestra con este fenómeno único, extraño y divertido a la vez, cuando cada año, cientos de cabras, por naturaleza trepadoras, se suben al árbol para alimentarse de los brotes, y cada año las cultivadoras bajan a las cabras para colectar el fruto con el que podrán fabricar el fino aceite.
Las antiguas leyendas, como suelen ser todas las que prevalecen en estas regiones del desierto y de los árboles están repletas de imaginación, y el argán evoca los tres niveles del cosmos (subterrá neo, medio y aéreo); además de los cuatro elementos básicos de la naturaleza (tierra, aire, agua, fuego). El subterráneo, compuesto con las raíces -muy extendidas y profundas en el argán que se hunden en la tierra desértica hasta encontrar agua, aquí está la tierra, alimento del árbol en donde viven microorganismos, pequeños animales, insectos y reptiles; el nivel medio en donde está el tronco y las ramas, en donde el aire se mueve para ventilar hojas, y por donde insectos y aves vuelan entre su ramaje; y el aéreo, con sus ramas orientadas hacia la luz del sol, el cielo y las estrellas, siempre con la esperanza de una benéfica y esperanzadora lluvia de verano, época en la que aparecen las hojas y los frutos -delicia de las cabras-, y el fuego -que también puede ser la luz y el calor del sol-, pero que de vez en cuando puede convertirse en una tragedia.
En resumen: las cabras trepadoras en los arganes constituyen una visión extraña y divertida de la naturaleza digna de relatarse y de ser observada por la magia de la imagen.
Chevalier, Jean / Gheerbrant, Alain. Diccionario de los símbolos (quinta edición 1995). Herder editores. Barcelona. España.
Gubernatis de, Angelo. Mitología de las plantas: leyendas del reino vegetal (primera edición del francés 2002). José J. de Olañeta, Editor. Palma de Mallorca / Barcelona. España.
Los productores de Lombardía, Trentino, Alto Adige, Veneto y EmiliaRomagna triunfaron una vez más en el World Olive Oil Competition.
Después de una temporada muy desafiante, un puñado de italianos del norte encontraron el oro en el 2022, ya que superaron sequías y heladas y hubo una producción de aceite de oliva extra virgen de gran calidad.
Los productores demostraron capacidad de recuperación frente a climas extremos. Sin embargo, en algunos casos la primavera y el verano poco generosos llevaron a rendimientos significativamente más bajos en la mayoría de las áreas del norte de Italia.
“Intentamos encontrar el aceite de oliva virgen extra que pudiera expresar las características de nuestra tierra” señaló Andrea Magnone, de Emilia-Romagna.
“Ha sido una zafra muy compleja en el escenario cambiante de los últimos años”, afirmó Furio Battelini, director técnico de Agraria Riva del Garda. Para agravar más los desafíos climáticos del 2021, Battelini agregó que “muchos árboles entraron en el año de descanso en el ciclo natural de producción alternativa del olivo”.
“El clima actual se ha vuelto más desafiante y más impredecible”, señaló Battelini. “En nuestra región, hubo alternativas, por lo que había productores de olivos produciendo menos en un área y otros produciendo más en otra
ubicación. Ahora, los efectos del clima son mucho más amplios, y solo podemos esperar que pronto regrese a ser como solía ser”.
Agraria Riva del Garda una vez más ganó un premio de oro por su 46° Parallelo, un orgánico aceite de oliva virgen extra. Las arboledas de este productor se encuentran en Trentino Alto Adige, sobre el lago de Garda, donde los Alpes contribuyen a tener un clima más templado.
“Ganar este premio ha sido una satisfacción, incluso más que en el pasado por la temporada que tuvimos”, dijo Battelini. “Para el año en curso, tenemos muchas esperanzas. También necesitábamos ver los niveles habíamos alcanzado en un año tan desafiante. Puedes seleccionar los frutos cuando tienes muchas aceitunas, pero si solo hay algunas, simplemente no tienes muchas opciones”.
Para el año en curso, tenemos muchas esperanzas, agregó Battelini. “Trabajamos mucho y con la experiencia, mejorando la poda y modulando la fertilización, con la esperanza que este sea un gran año”.
“Mi familia ha estado aquí desde 1880”, dijo el propietario Paul Willan. “y en los últimos años, aumentamos los árboles, de 100 a 1,000” .
“Tenemos suerte porque nuestras aceitunas tienen niveles de acidez muy bajos, lo que Willan atribuye a
Olivares en laderas y terrenos difíciles en Trentino, a orillas del Lago Garda, al pie de los Alpes, una región en el Norte de Italia que en 2020-2021 fue propicia para la producción de aceite de oliva virgen extra.

las características del suelo”. En una zona tan norteña, a una altitud de 385 metros sobre el nivel del mar, es una combinación buena con un resultado positivo para nuestro aceite de oliva virgen extra”.
“Hacer frente a los desafíos del clima, el terreno, sequías inusuales y la invasión de algunas plagas son retos difíciles de superar. En 2020 el clima fue seco, sin lluvias durante cuatro meses, lo que provocó gran estrés para los olivos y baja floración nunca antes vista. Luego, a principio de junio cayó gran granizada que redujo, al menos, a la mitad el número de flores. Por eso, es difícil predecir cómo será este año”.
“Ganar el premio, para nosotros ha sido una gran recompensa y la mejor confirmación del buen trabajo con el que estamos comprometidos” señaló Andrea Magnone, copropietaria de Emilia Food Love.
A pesar de las dificultades climáticas, los productores del norte de Italia lograron muy buen aceite de oliva extra virgen;
Los productores del Norte de Italia logran aceite de calidad a pesar de la sequía y las heladas
entraron en la competencia, y ganaron el premio que otorga el World Olive Oil.
(Oils and Fats International / Olive Oil Times.
Julio 2022)

El vidrio ha jugado un importante papel en la historia del conocimiento científico; material con significado especial en la química. Con motivo de la celebración del Año Internacional del vidrio convocado por las Naciones Unidas , Michelle Francl publicó el artículo “Heart of Glass” en Nature Chemistry en donde describe el uso del vidrio en los laboratorios. También destaca la descripción de los diferentes usos del vidrio elaborado por la Universidad de Burgos, España en su sección Materiales, 2022.
El vidrio, inventado en Siria hace unos 3,000 años es uno de los materiales más utilizados en la investigación química, especialmente a partir del siglo XVIII. Es un material refractario, resistente al calor, como es el de vidrio borosilicato,
resistente a los agentes químicos y bajo coeficiente de dilatación, lo que permite colocarlo en el quemador Bunsen para calentar o favorecer la combustión de muestras o reactivos. Matraces, placas Petri, embudos de decantación, balones de destilación, pipetas y probetas están hechas de vidrio por sus cualidades de resistencia y baja reactividad.
El vidrio está presente en el laboratorio en las lentes ópticas del microscopio, instrumento que hizo posible la microbiología, el análisis visual de elementos y sustancias invisibles al ojo humano. Desde las lentes que permiten observar con aumento hasta las láminas portaobjetos donde se colocan las muestras, el vidrio forma parte fundamental de la óptica de laboratorio. Con la invención del primer microscopio por parte de Anton Van Leeuwenhoek cuando se vieron y descubrieron por vez primera bacterias, protozoos, espermatozoides y glóbulos rojos.
Beneficios de la cristalería en el laboratorio
La cristalería ha precedido durante mucho tiempo en los laboratorios. Las
principales ventajas que ofrece son:
*Su alta claridad permite la visibilidad de los contenidos y la grabación precisa de los volúmenes.
· Los recipientes de vidrio sellados son impermeables a los gases atmosféricos, lo que evita la degradación oxidativa de los contenidos.
· Por ser inerte, no contribuye a la lixiviación de la contaminación, excepto en algunas especies iónicas.
· La cristalería es capaz de reutilizarse después de la limpieza prescrita.
· Los artículos de vidrio se esterilizan fácilmente.
· Los vasos y matraces de vidrio se pueden calentar utilizando placas calientes sin riesgo de rotura.
Al ser un material frágil, es propenso a la rotura accidental que puede provocar pérdida de muestras, derrames, fugas de productos e inclusive lesiones, por lo que deben manejarse con extremo cuidado y utilizar el equipo de laboratorio asignado para la seguridad de cada tipo de producto.
El vidrio es un material duro, frágil, transparente, y de alta estabilidad. Soporta muy bien las condiciones de frío o calor, es inerte e inalterable y tiene una gran resistencia a los agentes atmosféricos y químicos. Es 100% reciclable.

Todo indicaría que la elección y disfrute de alimentos es una decisión totalmente individual en la que únicamente interviene el gusto, el tipo de alimentos y el apetito de las personas; sin embargo, varios investigadores integrados en un equipo: Danni PengLi, Tjark Andersen, Graham Finlayson, Derek Victor Byrne y Qian Janice Wang, del Laboratorio Food Quality Perception and Society. Department of Food Science. Aarhus University. Denmark, estudiaron las diversas formas de elegir los alimentos de acuerdo con diferentes sonidos ambientales. Estudio publicado en Physiology & Behavior: The Impact of
Environmental Sounds of Food Reward (2022). Elsevier: 245: 113689).
Los sonidos pueden ser varios: a) propios de la naturaleza: por ejemplo, las olas del mar, los pájaros, o en una casa en la que no hay sonidos; b) el sonido de una ciudad, generalmente compuesto por el ruido que producen los automotores, voces y otros elementos; c) ruido y música, en restaurantes o cualquier otro recinto; por ejemplo, en una fiesta con diferentes tipos de sonidos, ruidos y música que influyen en la elección y disfrute de los alimentos ya sea porque crean un ambiente agradable para
quien los escucha o bien, se trata de un ambiente estresante y desagradable.
He aquí los objetivos y los resultados de la investigación. Los sonidos, el ruido y la música son de tal variedad e intensidad, que fue necesario acotarlos de una manera más simplificada; por tanto, se eligieron varios temas y su posible respuesta o hipótesis.
• El impacto de algunos sonidos de la naturaleza, en este caso el sonido del mar, en contraposición con el ruido de un restaurante por parloteos, risas y movimiento de la vajilla.
• Los sonidos agradables que aumentan el gusto explícito por los alimentos saludables (frente a los no-saludables).
• El ruido de un restaurante disminuye las diferencias entre la elección de alimentos saludables y no-saludables.
• El ruido de un entorno (frente a los sonidos de la naturaleza) induce a elecciones de alimentos con rapidez y con frecuencia no-saludables.
El deseo y el gusto son componentes que influyen en la elección de los alimentos; aunque, se manifiestan fundamentalmente en diferentes sustratos. Mientras que el deseo (antojo) denota una conducta anticipatoria, el gusto se asocia con experiencias ya consumadas. De hecho, el grado en que se valora un alimento está dentro comportamiento de las personas; aunque, el sonido puede interferir en este comportamiento y, en consecuencia, en la elección.
Además del sonido y el ruido, el deseo y el gusto, otros investigadores han estudiado factores externos que también influyen en la elección de los alimentos, como son la experiencia, el valor y tipo de alimento.
En relación con la comida y el sonido, en esta investigación se ha comprobado que el sonido del mar o el ruido del entorno (restaurante) y los sonidos fuertes (en comparación con los más suaves) disminuyen el gusto por el sabor de los comensales.
“Un sonido fuerte (ruido) puede disminuir la capacidad de prestar atención a elementos específicos de la experiencia”, que conducen a una alteración emocional, puesto que los sonidos fuertes elevan la excitación fisiológica y comportamiento psicológico y se asocian con la elección de los alimentos, lo que a su vez disminuye el gusto por la comida. Por el contrario, los sonidos ambientales asociados positivamente, como una música suave, el canto de los pájaros, el sonido de las olas del mar, de un riachuelo o una fuente, promueven la relajación emocional y, por tanto, conducen a una elección más cuidadosa de los alimentos y a un disfrute más pleno; por lo general, se eligen alimentos saludables.
Con objeto de ser más objetivos, los investigadores ampliaron las mediciones de relación sonido/alimento. Hicieron cambios tanto en el volumen como en el tipo de sonido de fondo para reforzar el comportamiento emocional de los paisajes sonoros y, en consecuencia, determinar el efecto auditivo combinado con el gusto por algún alimento y, en consecuencia, con la elección.
A partir de diferentes encuestas, se estudió el comportamiento de las personas en relación con la selección de sus alimentos con pruebas muy concretas: un ambiente en donde se emplearon sonidos suaves de la naturaleza -las olas del mar-, que pudieran conducir a la relajación y calma emocional; frente a otro ambiente en donde prevalecían sonidos (ruidos) fuertes -de un restaurante-, que conducían a un cierto nerviosismo o ansiedad, siempre asociados con el deseo y el gusto: la preferencia o el deseo de elegir un determinado alimento, tomando también en cuenta la hora del día, el hambre, el peso, y el estado de ejercicio.
Participaron ciento nueve estudiantes universitarios daneses de 18 a 35 años de la Universidad Aarhus, Dinamarca; todos con audición normal, una visión normal, sin alergias alimentarias y sin restricciones dietéticas. Fueron seleccionados 16 imágenes de alimentos “listos para comer”, de consumo habitual por los daneses. Se compararon con la información nutricional. Para acomodar la división entre alimentos saludables y nosaludables, las imágenes se dividieron según el contenido de grasas y calorías; además se equilibraron y se clasificaron en dulces y salados.
Se utilizaron dos paisajes sonoros ambientales: sonidos de la naturaleza (olas del mar) y ruido de restaurante (parloteo y

choque de vajilla). El paisaje sonoro de la naturaleza se eligió para inducir la relajación y el paisaje sonoro del ruido del restaurante se eligió para inducir la excitación. Para intensificar la respuesta emocional, los niveles de volumen de los paisajes sonoros se manipularon en función de una escala de volumen, según los estándares de la Unión Europea de Radiodifusión.
Como era de esperarse, los sonidos de la naturaleza fueron percibidos como más relajantes, en comparación con el ruido de los restaurantes que se percibieron como más excitantes.
El paisaje sonoro de la naturaleza se percibió como significativamente más relajante y más agradable (contra excitante y desagradable) en comparación con el paisaje sonoro de ruido en el restaurante.
No se detectó efecto de interacción significativo entre la condición de sonido ambiental y el tipo de alimento -saludable / no-saludable.
La condición de sonido de la naturaleza, a los participantes les gustaba más la comida saludable (vs. No-saludable), pero no se detectó diferencia alguna en el gusto de dos categorías de alimentos en el ruido, condición de sonido.

El consumidor asocia la manera de elegir y disfrutar los alimentos en relación con los sonidos y ruido del entorno
Además de ciertos parámetros metodológicos, los investigadores adoptaron cuatro categorías de alimentos: a saber, dulce bajo en grasa, salado bajo en grasa, dulce alto en grasa, salado alto en grasa. Sin embargo, debido a la naturaleza del objetivo del estudio, simplemente se estudiaron dos categorías: saludable / no-saludable.
Pregunta base: ¿Qué comida es la que más te apetece comer en este momento? La respuesta está asociada con los sonidos, los ruidos, y piden a los participantes respondan en la forma más rápida y precisa posible.
A cada participante se le presentaron las dos pruebas, elección de alimento con paisaje sonoro de la naturaleza, y elección con ruido de restaurante-.
Todos los datos fueron analizados en una computadora de acuerdo con las diferentes respuestas, con objeto de confirmar que los dos paisajes sonoros se percibieron de hecho como relajantes/excitantes. Se comparó un ‘sesgo de atracción’ para alimentos saludables/no-saludables, lo que resultó en un índice único; es decir, agrado explícito, deseo explícito, frecuencia de elección y deseo implícito.
A la luz del creciente reconocimiento de las influencias auditivas en la investigación sensorial y del consumidor y varios campos relacionados, se necesitan nuevas metodologías que permitan medir las hipótesis y que los resultados sean más precisos e integrales para comprender los efectos de amplio alcance del sonido en la percepción y comportamiento del comensal frente a los alimentos fundamentados en una realidad más directa.
En vista de que las hipótesis planteadas dieron como resultado los efectos deseados, se planteó la necesidad de contar con diferentes métodos, ya que en muchos casos el sonido no influyó en ninguna medida con el deseo; además, no se observó diferencia alguna en la elección de alimentos saludables y nosaludables con respecto al ruido de los restaurantes que es el prevalece en muchos de estos recintos.
Se comprobó que, en un estado psicológico más relajado, inducido fisiológicamente por los suaves sonidos de la naturaleza, los participantes son capaces de valorar y elegir explícitamente la alternativa más sana y ‘racional’. Por el contrario, con los ruidos de restaurante más fuertes que distraen de fondo, los recursos cognitivos de los participantes pueden cambiar, y llevar a un pensamiento menos reflexivo y posiblemente irracional sobre su valoración, elección y disfrute. De hecho, el tiempo rápido y el alto volumen de sonido, ambos elevan la excitación fisiológica, y reducen las capacidades cognitivas, como la precisión en las elecciones, el desempeño de las tareas y el pensamiento creativo.

